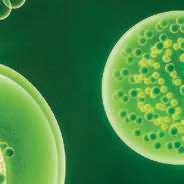

florence
téma
Hojení ran
Gynekologie
aktuálně
Udělení Ceny
PhDr. A. G. Masarykové
aktuálně
Novinky z Národního centra – naplňování Koncepce ošetřovatelství
aktuálně
Kaleidoskop z Chirurgického kongresu
téma
MUDr. Jana Racková: Sexuálně přenosná onemocnění a riziko mimoděložní gravidity

téma
Výskyt poranění kůže u novorozenců v roce 2022
téma
Modré nebo
růžové embryo
časopis obsahuje recenzované články
ODBORNÝ ČASOPIS PRO NELÉKAŘSKÉ květen–červen 2023 / ročník XIX ZDRAVOTNICKÉ PRACOVNÍKY 75 Kč / 4,50 € / www.florence.cz 3/23
Vážené čtenářky, vážení čtenáři, dostává se vám do rukou třetí číslo časopisu Florence. Ihned v úvodu vám představíme aktuality, na kterých pracuje Národní centrum, ať již v oblasti Koncepce ošetřovatelství nebo psychosociální podpory a edukace peerů a konzultantů pro zdravotníky, kteří to potřebují.
Navštívili jsme Chirurgický kongres v Praze, na kterém se sešly nejen kapacity z lékařské sekce, ale kde se také konal dvoudenní program pro nelékařské zdravotníky pod záštitou PhDr. Dagmar Škochové, MBA, z VFN v Praze, jehož součástí byla řada přínosných přednášek.

Musíme vás také upozornit na dopis redakci, který nám poslala Slávka Drgová. Někdy je potřeba si naše lidství a poslání sesterství připomenout, obzvláště příjemné je to potom v případech s dobrými konci.
Za jednu z hlavních kategorií jsme tentokrát zvolili hojení ran, a to při příležitost konference Hojení ran v kostce v Olomouci věnované dětským pacientům. Společně s autory jsme se zaměřili na hojení ran u dětí a novorozenců, jejichž kůže je velmi křehká a vyžaduje specifickou péči. Druhou kategorií je gynekologie, kde je jistě zajímavý pohled na etiku v asistované reprodukci z pera Mgr. Anny De Bayas Sanchez et al., nebo téma výživy při mnohočetném těhotenství.
Na našich webových stránkách jste možná zaznamenali kategorii in press. Jsou v ní vydávány články, které čekají na publikaci v tištěné podobě. Tentokrát například článek připomínající restrikce a opatření v době covidu od Mgr. Jaroslava Pekary, Ph.D.
Chtěla bych vám popřát příjemné čtení a také připomenout, že hlavní roli v našem časopise hrajete vy, naši čtenáři. Ať již v oblasti výběru témat, zaměření článků a spolupráce, ale také jako naši stálí nebo noví předplatitelé. Pokud máte o Florence zájem, neváhejte požádat své zaměstnavatele, aby vám časopis objednali.
A ještě bonus na závěr – na našich webových stránkách se již brzy objeví speciální videopodcasty. Pilotní díl je již spuštěn na našich sociálních sítích, najdete jej pod hlavičkou CareCast – CareComm. Takže neváhejte a pusťte si jej třeba do sluchátek na noční směně.

S přáním inspirativního čtení Mgr. Markéta Zbranková šéfredaktorka
Nezapomeňte, že časopis Florence nelze koupit na stáncích, lze objednat pouze na webu www.florence.cz/o-nas/predplatne/.
www.florence.cz
Ročník XIX, číslo 3, květen–červen 2023
Redakční uzávěrka pro toto číslo: 15. 5. 2023
Foto na titulní straně: Florence
Titulní strana: Mgr. Eva Provazníková, Vyšší odborná škola zdravotnická
a Střední škola zdravotnická v Ústí nad Labem
Staňte se naším fanouškem na Facebooku a Instagramu www.facebook.com/Florencecasopis casopis_florence
aktuálně
Udělení Ceny PhDr. A. G. Masarykové za přínos ošetřovatelství
11. května 2023 v hlavním sále Valdštejnského paláce Mgr. Eva Provazníková – vítězka Ceny PhDr. A. G. Masarykové Naplňování Koncepce ošetřovatelství Sdružené týmy interventů a peerů Národní centrum pokračuje v projektu „Čas na změnu“
Národní chirurgický kongres v Praze
hojení ran Výživa v procesu hojení ran u dětského pacienta 10–15 let Výskyt poranění kůže u novorozenců v roce 2022 Novorozenecká kůže, prevence jejího poranění a některé
kazuistiky
Stomií život nekončí Chemická nekróza u extrémně nezralého novorozence –kazuistika gynekologie
Sexuálně přenosná onemocnění a riziko mimoděložní gravidity
Výživa u vícečetného těhotenství Modré, nebo růžové embryo?
Etika v asistované reprodukci
recenzované články
Ošetrovateľská starostlivosť u pacienta s dekubitom v domácom prostredí
Simulace ve výuce porodních asistentek
studium a výzkum
Motivace k výkonu profese všeobecné sestry v intenzivní péči
historie
Culle per la vita

dopis redakci
Komunikací k novému životu právní poradna
Jak to má běžný občan s povinností poskytnout první pomoc?
angličtina
1 obsah florence 3/23
2 3 4 6 7 8 12 15 18 21 22 24 27 29
Výživa v procesu hojení ran u dětského pacienta 10–15 let 12 editorial 32 36 38 42 45 46 48
Udělení Ceny PhDr. A. G. Masarykové za přínos ošetřovatelství 11. května 2023 v hlavním sále Valdštejnského paláce
Redakce Florence
Slavnostní vyhlášení se konalo v reprezentativním sále Valdštejnského paláce v budově Senátu Parlamentu ČR při příležitosti Mezinárodního dne sester za účasti ministra zdravotnictví prof. MUDr. Vlastimila Válka, hlavní sestry České republiky Mgr. Alice Strnadové, MBA, náměstka ministra zdravotnictví Bc. Josefa Pavlovice, senátora MUDr. Romana Krause, MBA, a nového náměstka ministra zdravotnictví Václava Pláteníka. Každý z nich zúčastněným sestrám poděkoval za jejich práci a neutuchající úsilí v péči o pacienty a rozvoj oboru.
„Naše dnešní setkání berte prosím jako poděkování. Vážíme si vaší spolupráce a jsme velmi rádi, že vznikly pracovní skupiny a týmy, kterým se daří posouvat obor ošetřovatelství dále, za což vám ze srdce děkuji,“ uvedla Strnadová, která všem sestrám popřála hodně štěstí, zdraví, osobní spokojenosti a pracovních úspěchů.
Cena PhDr. A. G. Masarykové za přínos ošetřovatelství je každoročně udělována při příležitosti Mezinárodního dne sester za významný přínos ošetřovatelství. „Vnik a udílení ceny považuji za velmi přínosné a správné,“ uvedl ministr Válek. Všechny tři oceněné dámy jsou významné,
výrazné a inspirativní osobnosti ve svém oboru, oceňované svými spolupracovníky a pracující v oboru více než 20 let.
1. místo Mgr. Eva Provazníková
2. místo Mgr. Nina Müllerová
3. místo Mgr. Vladimíra Svobodová
Mgr. Vladimíra Svobodová z Vyšší odborné školy zdravotnické Suverénního řádu maltézských rytířů v Praze se celý svůj profesní život věnovala péči o pacienty v preterminální a terminální fázi onemocnění, věnuje se paliativní péči. Ve snaze nabídnout pacientům co nejkvalitnější paliativní péči založila v roce 2016 Nadační fond Hospic Help, který má za cíl zlepšení životních podmínek osobám v paliativní péči.
Kolegové oceňují její lidský přístup k pacientům, spolupracovníků i rodinám, její znalosti a zkušenosti, které aktivně předává studentům oboru diplomovaná všeobecná sestra na VOŠZ SŘ MR. Podílí se také na projektech Nadačního fondu Yoga Help.
Mgr. Nina Müllerová z Fakultní nemocnice Plzeň zasvětila celý svůj život profesi ošetřovatelství. Od roku 1974 postupovala od profese všeobecné sestry, hlavní sestry, manažerky kvality až k tvorbě ošetřovatelských standardů a publikační činnosti. Působí
v České asociaci sester a dlouhodobě i v čele Plzeňského regionu a prezidiu. Své odborné i manažerské schopnosti využívá při zavádění systému kvality a vedení pracovních skupin, podílí se na prevenci výskytu dekubitů, pádů, na elektronizaci zdravotnictví a výuce zdravotnických pracovníků. Mgr. Nina Mullerová působí také jako konzultantka Národního centra ošetřovatelství a nelékařských zdravotnických oborů v Brně, kde přispívá cennými radami k tvorbě vzdělávacích programů certifikovaných kurzů nebo specializačního vzdělávání a jejich vysoké úrovni založené na medicíně založené na důkazech. Je členkou expertní skupiny přípravy Koncepce ošetřovatelství do roku 2030.
Mgr. Eva Provazníková z Vyšší odborné školy zdravotnické a Střední školy zdravotnické v Ústí nad Labem pracuje jako dětská sestra od roku 1988. Nastoupila na pozici dětské sestry na novorozeneckém oddělení JIP a dále se odborně vzdělávala. Získala magisterský titul na 1. LF UK v Praze a začala vyučovat ošetřovatelské obory se zaměřením na praktické zkušenosti. Od roku 2009 pracuje na pozici zástupkyně ředitelky. Ve škole vychovala řadu všeobecných a dětských sester, spolupracovala se Zdravotnickou záchrannou službou Ústeckého kraje i s Masarykovou nemocnicí a při výuce se vždy snažila smysluplně ovlivňovat náplň vzdělávacích programů tak, aby odpovídaly potřebám v terénu.
V závěru odpoledne poděkovaly hlavní sestře Mgr. Alici Strnadové, MBA, ředitelka Národního centra ošetřovatelství a nelékařských zdravotnických oborů PhDr. Mgr. Michaela Hofštetrová Knotková společně s proděkankou pro nelékařské studijní programy a informační technologie LF MU v Brně prof. PhDr. Andreou Pokornou, Ph.D., za činnost a přínos v oboru ošetřovatelství a předaly jí kytici. Voňavou růži dostaly i všechny účastnice slavnostního předávání.
Všem oceněným gratuluje i časopis Florence.

2 florence 3/23 foto: Florence
aktuálně
Slavnostní předání Ceny PhDr. A. G. Masarykové
Mgr. Eva Provazníková –vítězka Ceny PhDr. A. G. Masarykové
Čeho si nejvíce vážíte?
Výběru oboru povolání, které mě stále baví, a výborných kolegů, které mám vedle sebe ve škole i v nemocnici.
Co považujete za nejdůležitější při tvorbě vzdělávacích programů?
Provázanost s praxí. Absolventi všech oborů jsou prakticky uplatnitelní a jejich poznatky odpovídají moderním trendům medicíny ve všech stupních zdravotnického vzdělávání.
Jak funguje zařazování odborníků do výuky, které prosazujete?
Dlouhodobě spolupracujeme s Krajskou zdravotní, a. s., s privátními zdravotnickými zařízeními, lékárnami a tak dále a spolupráce byla po mnoho let vynikající. V posledních letech nám odborníci lékařských oborů přecházejí vyučovat na vysokou školu, kde mají možnost akademického růstu, což nám ale mnohdy činí problémy při zajištění výuky.
Co se Vám povedlo, na co jsem hrdá? Myslím, že je to velký počet absolventů – záchranářů, sester, ale i studentů ostatních oborů, kteří po absolvování zdravotnické školy nastupují do praxe.
Co ještě rozvíjet, prohlubovat? Určitě provázanost mezi vysokými a vyššími odbornými školami. Aby absolventi vyšší odborné školy, kteří chtějí získat titul Bc., mohli být přijati do 3. ročníku bakalářského studia, kde by dostudovali předměty, které jim chybí. Studium 1. ročníků je velmi podobné a začínat zase od 1. ročníku ekonomicky nerentabilní.
Chtěla byste ještě něco k ocenění dodat? Předávání cen bylo v krásných prostorech Valdštejnského paláce. Ocenění by si zasloužili všichni, kdo pracují v pomáhajících profesích,
Vážené dámy, vážení pánové, dovolujeme si Vás pozvat na první národní konferenci

, která se bude konat 23.–24. října 2023 v hotelu lnternational v Brně
Záštitu nad konferencí převzal ministr zdravotnictví ČR prof. MUDr. Vlastimil Válek, CSc., MBA, EBIR.
www.zdrav-edu.cz







Cílem konference je představení možných směrů v oblasti vzdělávání zdravotnických pracovníků. Významná část sdělení bude věnována analýzám stavu vzdělávání ve zdravotnictví, personálním kapacitám ve zdravotnictví a strategiím ministerstva zdravotnictví v optimalizaci vzdělávání. Součástí programu budou tematické workshopy určené účastníkům konference. Protože je v Brně skvěle vybavené simulační centrum při LF MU, nabízíme účastníkům konference a zájemcům z řad studentů zdravotnických oborů exkurzi tohoto centra.
Věříme, že Vás program konference zaujme.
Těšíme se na Vaši účast a setkání s Vámi programový výbor konference

3 aktuálně
Redakce Florence
INZERCE
Naplňování Koncepce ošetřovatelství
Informace o činnosti pracovní skupiny Kvalita a bezpečí v rámci Akčního plánu Koncepce ošetřovatelství.
Mgr. Nina Müllerová, Mgr. Dita Svobodová, Ph.D., PhDr. Mgr. Michaela
Hofštetrová Knotková et al.
NCO NZO Brno
Úvod
Nová Koncepce ošetřovatelství byla schválena dne 27. dubna 2021 vedením Ministerstva zdravotnictví (MZ ČR) a vyšla ve Věstníku č. 6/2021 (MZ ČR, Věstník 6/2021). Koncepce ošetřovatelství je výsledkem spolupráce MZ ČR se všemi klíčovými zainteresovanými stranami a popisuje nejen současný stav českého ošetřovatelství, ale především navrhuje jeho budoucí vývoj.
Nová vize ošetřovatelství by se měla realizovat prostřednictvím tří hlavních strategických cílů, které jsou rozpracovány do devíti specifických cílů. Z hlavních, globálních cílů je koncepce zaměřena především na vzdělávání a praxi založené na spolupráci všech zainteresovaných stran, bezpečnou úroveň personálního obsazení a kvalitu ošetřovatelské péče a na posílení postavení sester ve společnosti.
Byl vypracován Akční plán ke Koncepci ošetřovatelství (Databáze strategií, 2022), který představuje nástroj k dosažení devíti specifických cílů prostřednictvím několika skupin odborníků vedených hlavním koordinátorem a Odbornou radou ošetřovatelství MZ ČR. Dokument obsahuje několik příloh s informacemi o hierarchické struktuře prací, harmonogramu a plánovaném rozpočtu. Dále obsahuje soubor sledovaných indikátorů, řídící a organizační strukturu implementace, systém řízení rizik, systém monitorování a evaluací a také komunikační plán. Oba dokumenty, včetně první hodnoticí zprávy, jsou dostupné veřejnosti (Databáze strategií, 2022).
Implementační plán je živým dokumentem, který reaguje na změny vnějšího prostředí a na poznatky realizace, které vyplývají z praxe. Pracovní skupiny se v průběhu realizace specifických cílů mohou setkat s novými poznatky či s nově identifikovanými
potřebami praxe, které mohou vyústit v potřebu aktualizace dílčích cílů. Naše skupina se podílí na realizaci cíle číslo 2 – Bezpečná úroveň personálního obsazení a kvalita ošetřovatelské péče.
První výsledky činnosti pracovní skupiny pro kvalitu a bezpečí Pracovní skupina pro kvalitu a bezpečí ošetřovatelské péče má osm členů. Předsedou skupiny je Mgr. Nina Müllerová, místopředsedou Mgr. Dita Svobodová, Ph.D., a dalšími členy jsou Mgr. Alice Strnadová, MBA, PhDr. Mgr. Michaela Hofštetrová Knotková, Mgr. Dana Vaňková, Mgr. Pavel Kurek, DiS., Mgr. Regína Gavlasová, DiS., a Bc. Vojtěch Fišera.
Cíle skupiny:
Graf 1 Pracujete ve vašem zařízení s „Nadnárodními ošetřovatelskými postupy“ vydanými MZ ČR? aktuálně
a) provést Analýzu sledování kvality ošetřovatelské péče prostřednictvím standardů ošetřovatelské péče, Národních ošetřovatelských postupů (NOP) a Klinických doporučených postupů (KDP);
b) revidovat kompetence v ošetřovatelském systému;
c) provést kořenové analýzy jednotlivých nežádoucích událostí. Tento plán má být realizován do konce roku 2024.
V rámci skupiny jsme připravili dotazník pro poskytovatele zdravotních služeb se zaměřením na využívání stávajících NOP a návrhy na nové oblasti, které vyžadují standardizaci. V návaznosti na výsledky dotazníku realizujeme ve spolupráci s garanty postupnou revizi stávajících NOP s požadavkem na aktualizaci. Dotazníkem jsme ověřili, jaká je praxe při využívání NOP a do jaké míry jsou využívány k úpravě již vytvořených lokálních postupů u jednotlivých poskytovatelů. Dále jsme ověřili, které z NOP jsou využívány v praxi nejčastěji a jaké oblasti jsou v praxi považovány za rizikové a bylo by žádoucí je podpořit novými standardními postupy. V neposlední řadě nás zajímalo, zda již byly některé NOP využity i při řešení stížností či sporů.
Pro naplnění tohoto cíle jsme zvolili jako první krok dotazník. Dotazník byl vytvořen elektronicky a e-mailem bylo osloveno 48 respondentů z různých typů poskytovatelů zdravotních služeb. Návratnost, respektive vyplnění elektronického dotazníku byla poměrně vysoká – 81,25 % (39/48). Nejvíce odpovědí (66,7 %) bylo od poskytovatelů zdravotních služeb zřizovaných krajem, další v pořadí jsou zařízení zřizovaná ministerstvem (23,1 %) a ve zbývajících 10,2 % se jednalo o zařízení soukromá či zřizovaná městem. Z hlediska pozice respondentů se ve velké míře jednalo o náměstkyně ošetřovatelské péče (69,2 %) nebo hlavní sestry (17,9 %), ve zbývajících 10,9 % se jednalo o manažery kvality, vrchní sestry nebo odborníky v oblasti ošetřovatelství.
Výsledky
Ano, využíváme je a plně aplikujeme v ošetřovatelských postupech nemocnice
Ano, využíváme je a částečně zapracujeme některá doporučení v ošetřovatelských postupech nemocnice Nevyužíváme je a vytváříme ošetřovatelské postupy specifické pro naši nemocnici
Na otázku „Pracujete ve vašem zařízení s NOP vydanými MZ ČR?“ odpovědělo 35,9 % respondentů ANO, využíváme je a plně aplikujeme v ošetřovatelských postupech, 64,1 % respondentů odpovědělo ANO, využíváme je a částečně zapracujeme některá doporučení v ošetřovatelských postupech nemocnice (graf 1).
Z žádosti „Prosíme, zda byste označil/la tři NOP, které považujete za nejpřínosnější pro vaši nemocnici“, jsme získali následující přehled (graf 2). Na prvních šesti místech jsou tyto postupy:
4 florence 3/23
39 odpovědí 64,1 % 35,9 %
Sdružené týmy interventů a peerů
Nová cesta poskytování psychosociální podpory – systém psychosociální intervenční služby (SPIS) a efektivní poskytování psychosociální podpory ve zdravotnictví
NCO NZO Brno
Vsouladu s metodickým doporučením Ministerstva zdravotnictví (MZ) ČR o poskytování psychosociální podpory ve zdravotnictví z roku 2019 jsou jednotlivými poskytovateli zdravotních služeb budovány týmy zajišťující její dostupnost. Pracovníci zapojení do týmů psychosociální podpory, zdravotničtí peeři a zdravotničtí interventi, jsou vzděláváni v ministerstvem zdravotnictví akreditovaných kurzech (certifikovaných kurzech), probíhajících v brněnském Národním centru ošetřovatelství a nelékařských zdravotnických oborů. Poskytují základní a první psychickou podporu jak takzvaně sekundárně zasaženým – blízkým pacientů a pozůstalým (interventi), tak samotným zdravotnickým pracovníkům (peeři). Služba se v souladu s dokumentem MZ postupně etabluje napříč resortem, přičemž jednotliví peeři a interventi jsou sdružováni v rámci Systému psychosociální intervenční služby (SPIS). Zapojení psychosociální podpory se v uplynulých letech plně osvědčilo nejen v případě velkých mimořádných událostí, jako byl aktivní střelec ve Fakultní nemocnici Ostrava či pandemie covid-19. Události s náhlými, případně tragickými či dětskými úmrtími, které s sebou nesou nadlimitní psychickou zátěž pro zúčastněné, se v prostředí zdravotnictví odehrávají prakticky denně. V řadě z nich je zapotřebí poskytnout psychicky zasaženým základní psychickou podporu bezprostředně po vzniku psychické zátěže, případně zajistit i další směrování těchto osob do následné odborné péče. Právě tuto činnost naplňují zdravotničtí interventi a peeři.
Provedení zmíněné podpory výrazně snižuje nutnost farmakologické medikace zasaženého, nutnost vyšší a finančně náročnější péče specializace psychiatr a klinická psychologie. Kvalitní a včasné ošetření stresového stavu vede k rychlejšímu vyrovnání se s traumatickou zátěží, je prevencí vzniku duševního i somatického onemocnění. Zároveň je plně v souladu s reformou duševního zdraví v ČR, která
podporuje včasné ošetření psychiky, a s dalšími strategiemi MZ ČR (Zdraví 2030, Koncepce ošetřovatelství).
Situace s potřebou zásahu především zdravotnických interventů, ale leckdy i peerů se přitom u poskytovatelů lůžkové péče i v terénu odehrávají bez možnosti plánovat je – nastávají v kteroukoli hodinu, v pracovních dnech i během víkendů a svátků. Jelikož se jedná o poskytnutí akutní psychické podpory, která je potřebná bezprostředně po vzniku zátěžové události, ukazuje se jednoznačná nutnost zajistit dobrou dostupnost zmíněné služby.
Jednotliví poskytovatelé zdravotních služeb disponují různými počty vyškolených pracovníků v certifikovaných kurzech s dovedností poskytování intervenční a peer podpory. Odvíjí se jednak od délky doby, po kterou již zmíněnou službu rozvíjejí, stejně jako od velikosti dané organizace či možnosti proškolení dalších vhodných osob. Výcviky nových interventů a peerů jsou finančně poměrně náročné a kurzy jsou dlouhodobě zcela naplněny zájemci z celé ČR. Kompletními týmy disponují dosud jen některé organizace.
Budovat proto kompletní tým u každého, i velikostí menšího poskytovatele lůžkové péče, se nejeví jako finančně udržitelné a realizovatelné s ohledem na kapacitu zapojených zdravotnických pracovníků. Rovněž základní příprava a udržitelnost
Ředitelka Národního centra PhDr. Mgr. Michaela Hofštetrová Knotková při zahájení výcviku interventů

odbornosti každého peera a interventa s sebou nese průběžné náklady. Logickým krokem zohledňujícím potřebu poskytování psychosociální podpory se současným pokrytím potřeb všech poskytovatelů zdravotních služeb v daném regionu proto může být vytvoření sdruženého týmu, který propojí zdravotnické peery a interventy jednotlivých poskytovatelů. Funkčnost sdruženého týmu v současné době je ověřována v Moravskoslezském kraji (MSK).
Krajský tým psychosociální intervenční služby v Moravskoslezském kraji
Na základě schválení rady kraje byl v MSK vytvořen a do provozu v listopadu 2022 uveden Krajský zdravotnický intervenční tým. Jeho činnost zahrnuje poskytování první psychické a psychosociální pomoci, a to prostřednictvím činnosti zdravotnických interventů a peerů v terénu i krajských organizacích. K dispozici je tedy mobilní tým psychosociální podpory, připravený pro zásah kdekoli na území MSK. Jeho pracovníci jsou připraveni k zásahu v nepřetržité pohotovosti. Poskytnutí služby je bezplatné, provoz finančně podporuje MSK.
Krajský zdravotnický intervenční tým funguje na vyžádání, nejčastěji na základě indikace posádky zdravotnické záchranné služby (ZZS) v terénu nebo oddělení poskytovatele lůžkové péče, pokud daný poskytovatel zdravotních služeb aktuálně nemá pro poskytnutí akutní psychické podpory dostupného vlastního pracovníka. Požadavek na zásah zdravotnického interventa nebo peera je směřován na krajské zdravotnické operační středisko ZZS, které ihned na místo vysílá nejbližšího dostupného pracovníka v pohotovostní službě. Mobilní tým je složený ze členů ZZS MSK a zaměstnanců poskytovatele lůžkové péče v regionu.
Propojením peerů a interventů jednotlivých poskytovatelů lůžkové péče a zdravotnické záchranné služby tak byla vytvořena velice flexibilní, výborně dostupná a funkční síť, která je k dispozici zasaženým osobám, a to jak z řad veřejnosti, tak i zdravotnických pracovníků. Krajský intervenční
6 florence 3/23 aktuálně
foto: NCO NZO Brno
Kvalitní a včasné ošetření stresového stavu vede k rychlejšímu vyrovnání se s traumatickou zátěží
tým výrazně zlepšuje možnost včasného poskytnutí první psychické pomoci v resortu zdravotnictví na území MSK.
Krajský mobilní tým má za sebou prvních 6 měsíců činnosti, během kterých poskytl psychickou podporu při 60 událostech, a to 152 zasaženým
osobám. Systém počítá s dojezdem pracovníka v okruhu přibližně 30 km, tedy jeho dostupností na cílovém místě v řádu několika desítek minut, a to kdekoli na území regionu. Jeho členové, kterých je v MSK aktuálně 37, jsou pro potřebu zásahu k dispozici v nepřetržité pohotovosti.

„Čas na změnu“
Mezi události, do kterých byl krajský intervenční tým již zapojen, patří kupříkladu důlní neštěstí, při němž kromě úmrtí jednoho horníka došlo také ke zranění jedenácti dalších. Ve třech zdravotnických zařízeních, do nichž byli následně přepraveni, probíhala vzhledem k silným projevům akutní stresové reakce včasná intervence. Jiným příkladem byla peer podpora zasaženého zdravotnického týmu oddělení nemocnice, kde došlo k náhlému úmrtí kolegyně mladého věku. I v tomto případě se na zajištění intervence podíleli pracovníci krajského intervenčního týmu. Systém psychosociální intervenční služby je v rámci MSK plně využíván. Svědčí o tom skutečnost, že zdravotničtí peeři a interventi odvedli za uplynulý půlrok celkem, tedy v rámci krajského týmu i jednotlivých organizací, 241 intervencí, z toho osm desítek bylo v rámci peer podpory, v ostatních případech šlo o sekundárně zasažené blízké a pozůstalé pacientů.
Národní centrum ošetřovatelství a nelékařských zdravotnických oborů pokračuje v realizaci interního projektu „Čas na změnu“ směřujícího k naplnění vize „Stát se znalostní organizací, která bude vyhledávaným partnerem, odborníkem a leaderem v oblasti zvyšování odborné a etické úrovně pracovníků ve zdravotnictví i zdravotně orientované laické veřejnosti.“
NCO NZO Brno

VNárodním centrum ošetřovatelství a nelékařských zdravotnických oborů (Národní centrum) samozřejmě nezahálíme a usilovně pracujeme na tom, aby se naše vize naplňovala. Nastavujeme nové procesy, hledáme nové příležitosti, rozvíjíme se.
Mezi zásadní novinky posledního období patří schválení nové zřizovací listiny, nového statutu a nové organizační struktury Ministerstvem zdravotnictví. Postupně tak připravujeme kroky k vytvoření nové podoby Národního centra s důrazem na stabilitu, profesionalitu a respekt. Nově se budeme potkávat na Úseku vzdělávání a Úseku profesního rozvoje
zdravotnických pracovníků, nové projekty pro vás bude připravovat a ve spolupráci s ostatními úseky realizovat Projektová kancelář. Samostatně bude působit Odbor Hotelu Centrum a Odbor služeb. Naše účastníky vzdělávání budou s úsměvem vítat koordinátorky na Odboru koordinace vzdělávání. Vzhledem k participaci na implementaci Koncepce domácí péče a k velkému zájmu o oblast zdravotně sociálního / sociálně zdravotního pomezí a domácí péče vznikne nová Katedra domácí péče a podpory v sociálních službách. A to ještě není vše. Dalším výrazným krokem je nová vizualizace Národního centra. Dali jsme našemu logu modernější kabátek, modernější barvy a především příběh.
Příběh loga NCO NZO vychází z myšlenky propojení lidí a vzájemné lidské spolupráce. S odkazem na
původní logo je uprostřed vyobrazen zdravotnický kříž, který vychází ze symboliky charitativního řádu, jehož hlavním posláním byla péče o nemocné a poutníky. V našem pojetí kříž vyjadřuje ošetřovatelství, zdravotní péči a propojení lékařských i nelékařských zdravotnických pracovníků. Čtyři barevné fragmenty okolo kříže definují Národní centrum. Barevně odlišeno je ošetřovatelství (zelená barva) a nelékařská zdravotnická povolání (modrá barva). Fragmenty představují všechny osoby, které působí nebo prošly Národním centrem, a jejich vědomosti využívané v rámci jejich profesí, jež pomyslně „objímají a chrání“ veškeré zdravotnictví.
7 aktuálně
doc. Ing. Pavla Staňková, Ph.D., Marketing
Národní centrum pokračuje v projektu
Národní chirurgický kongres v Praze
Součástí chirurgického kongresu, který se konal v květnu v Praze, se letos stal i rozsáhlý odborný program Sekce zdravotnických pracovníků nelékařských oborů.
Ve dnech 10.–12. května 2023 proběhl v Cubex centru Praha Národní chirurgický kongres uspořádaný výborem České chirurgické společnosti, odbornými společnostmi a Českou asociací sester (ČAS). Za organizační výbor účastníky uvítal předseda prof. MUDr. Zdeněk Kala, CSc., který vyzdvihl důležitost a význam tohoto setkání. Účastníky přivítal také ministr zdravotnictví prof. MUDr. Vlastimil Válek, CSc., za sekci nelékařských zdravotnických pracovníků (NLZP) organizátorka sekce PhDr. Dagmar Škochová, MBA, vedoucí Odboru vzdělávání VFN v Praze.
„Chirurgické kongresy jsou pořádány od roku 1921 a jejich nespornou výhodou je možnost osobního setkání a sdílení zkušeností,“ zmínil čestný člen organizačního výboru a předseda přednáškových sekcí prof. MUDr. Pavel Pafko, DrSc. Během slavnostního zahájení byly uděleny ceny ministra zdravotnictví za zásluhy pro rozvoj oboru.
Státního zdravotnického ústavu Praha o možnostech likvidace legionelly v rozvodech vodovodních sítí ve zdravotnických zařízeních. Připomněla tento záludný zdroj infekcí a potřebu jeho eliminace. O komplikacích a problematice podávání antibiotik pohovořila PharmDr. Irena Netíková Štenglová, Ph.D., z VFN v Praze. Z jiného soudku pocházela kazuisti-
mohly prohlédnout edukační programy pro pacienty i zdravotníky, jako jsou například speciální polohovací lůžka, nebo si v praxi vyzkoušet správný postup při péči o chronickou ránu. K dispozici byly modely a bylo možné si vyzkoušet i proplachovou podtlakovou terapii.
Další přednášky se dotkly témat paliativní péče, osob bez přístřeší nebo osob docházejících do azylového domu. Ke klasickým chirurgickým tématům se opět vrátily přenášející z Olomouce, které představily srovnání klasické a robotické pankreatektomie nebo chirurgickou stabilizaci hrudní stěny.
PhDr. Dagmar Škochová, MBA, při slavnostním zahájení sekce pro nelékařské zdravotníky spolu s čestným hostem, PhDr. Martinou Šochmanovou, MBA, prezidentkou ČAS
Speciální přednášku na úvod přednesl prof. RNDr. Ladislav Dušek, Ph.D., ředitel ÚZIS ČR, který ukázal informace z registru a upozornil na to, o jak velký objem péče se jedná, jak jej komplikuje stárnutí populace a jakých je i přesto dosahováno výsledků.

V letošním roce dostal velký prostor i program NLZP, který zahrnoval několik přednáškových bloků během dvou dní v samostatném sále včetně edukačních workshopů a prezentací pacientských organizací. Čestným hostem byla i současná prezidentka ČAS PhDr. Martina Šochmanová, MBA.
V prvním bloku přednášek pro NLZP zazněla například přednáška MUDr. Věry Melicharčíkové, CSc., ze
ka komplikované stomie u mladého muže s onemocněním motýlích křídel, kterou přednesla Bc. Blanka Pupíková z Chirurgické kliniky FN Ostrava. Její dojemné nasazení při péči o komplikovaného pacienta vzbudilo zasloužený dlouhotrvající potlesk. Kazuistiky přinesla také Mgr. Monika Antonová z FN Brno, která ukázala, jak lze pečovat o těhotné pacientky se stomií.
Druhý blok se soustředil na problematiku urgentního příjmu a ošetření pacienta v přednemocniční péči. Mgr. Petr Karmazín, MBA, L. L., z ÚVN Praha vysvětlil systém takzvaného walking blood bank a jeho použití během současné války na Ukrajině.
Po dobu polední přestávky proběhly workshopy, na nichž si účastnice
Páteční blok se věnoval syndromu diabetické nohy a jeho léčbě pomocí vlhkého hojení. Mgr. Markéta Koutná, Ph.D., z VFN v Praze souhrnně představila roztoky používané při hojení ran. Příjemným zpestřením byl pohled na péči poskytovanou Rehabilitačním ústavem v Brandýse nad Orlicí představený jeho ředitelkou Mgr. Světlanou Jeřábkovou nebo kazuistika pacientky po TEP ramene z pohledu fyzioterapeuta a ergoterapeuta.
Všechny přednášející vyzdvihly pomoc robotiky v oblasti rehabilitace.
Nemůžeme také opomenout odpolední přednášku doc. PhDr. Laury Janáčkové, CSc., z VFN v Praze na téma Optimizmus, zbraň proti depresi a úzkosti. Jak zvládnout náročné situace? Vlastním úhlem pohledu a úpravou vnitřního nastavení.
8 florence 3/23
Redakce Florence
aktuálně
Velký prostor dostal program NLZP, který zahrnoval několik přednáškových bloků, edukačních workshopů a prezentací pacientských organizací.
foto: redakce Florence
hojení ran téma
Výživa v procesu hojení ran u dětského pacienta 10–15 let

Souhrn:

Klíčová slova:
Summary:
Keywords:
Hojení ran je velmi složitý proces. Správně nastavená výživa – dostatek makro- a mikronutrientů, esenciálních aminokyselin, zejména argininu a glutaminu, vlákniny, nenasycených mastných kyselin (omega-3, omega-6) – má velký vliv na revitalizaci poškozené tkáně.
výživa, hojení ran, bílkoviny, arginin, glutamin, sacharidy
Nutrition in the process of wound healing in a child patient aged 10–15 years
















Wound healing is a very complex process. Proper nutrition includes enough macro and micronutrients, essential amino acids – especially arginine and glutamine, fiber, unsaturated fatty acids (omega-3, omega-6). ese all have a great effect on the revitalization of damaged tissue. nutrition, wound healing, proteins, arginine, glutamine, carbohydrates
Mgr. Jana Macková, Oddělení léčebné výživy
FN Motol
Výživa je jedním z mnoha faktorů ovlivňujících pozitivně, či negativně proces hojení ran. Pozitivním účinkem je zde myšleno dostatečné množství substrátů pro nově se tvořící tkáň.
Špatný stav výživy zvyšuje riziko
vzniku chronických defektů. V důsledku ztráty tělesné hmotnosti a úbytku podkožního tuku více vystupují kostní
výčnělky. V oblasti kostních výčnělků, které jsou ve styku s pevnou podložkou, se zvyšuje působení tlaku na kůži a podkožní tkáně. Špatný stav výživy dále může vést k otoku tkáně, a tak snižovat prokrvení v postižené oblasti, k úbytku svalů, a tím snižovat pohyblivost nemocného.

Nejen malnutrice, ale i nadměrná nutrice je pro léčbu chronických defektů nežádoucí. Vysoký přívod živin může až nepříznivě ovlivnit metabolizmus, což se následně projeví negativně v efektivitě léčby. Hovoříme o overfeeding syndromu. Jde o stav, kdy je



lidské tělo přetěžováno živinami za vzniku hyperglykemie, hyperkapnie, steatózy jater a kosterního svalstva a mnoha dalším změnám.
Sacharidy

Cukry (sacharidy) jsou hlavním zdrojem energie nebílkovinné povahy, glukóza je pak zásadním zdrojem energie pro centrální nervový systém. Sacharidy jsou hlavním zdrojem energie pro vytvoření adenozintrifosfátu (ATP), který poskytuje energii pro angiogenezi a syntézu kolagenu. Příjem sacharidů by měl

12
foto: Freepik
Souhrn:
Výskyt poranění kůže u novorozenců v roce 2022
Článek zmiňuje výsledky šetření výskytu poranění kůže u novorozenců a jejich léčby, které proběhlo v roce 2022 v perinatologických centrech a na dalších třech neonatologických pracovištích v České republice. Výsledky porovnává s podobným šetřením, které již proběhlo v roce 2020. Z výsledků šetření v roce 2022 vyplynulo, že se celkový počet poranění kůže novorozenců snížil z původních 537 (v roce 2020) na 428 a z uvedených typů poranění se snížil především počet extravazací/infiltrací, které vznikají jako komplikace intravenózně podaných roztoků a léků. Naopak se zvýšil počet erozí/exkoriací po nešetrném stržení adheziv nebo elektrod a počet dekubitů vzniklých následkem imobility nebo po použití zdravotnických prostředků pro neinvazivní plicní ventilaci. Rovněž se zvýšil počet kontaktních podráždění po dráždivých mycích prostředcích nebo dezinfekci. Z použitých léčebných metod převážilo vlhké hojení ran nad metodou klasickou, která byla v roce 2020 nejpoužívanější. Jednou byla použita také metoda podtlaková.
Klíčová slova:
Summary:
poranění kůže, novorozenec, výsledky šetření, ošetřování a léčba
Incidence of skin injuries in newborns in 2022
e article deals with the results of the survey of neonatal skin injury incidence and methods of their treatment, which was conducted in 2022 in the perinatology centers and at three additional neonatology departments in the Czech Republic. e results are compared with the similar survey that was already carried out in 2020. e results of the survey in 2022 showed that the total number of skin injuries in newborns decreased from the original 537 (in 2020) to 428. As for the mentioned types of skin injuries, the number of extravasations/infiltrations, which arise as complications of intravenously administered solutions and drugs, mainly decreased. On the contrary, the number of erosions/excoriations after insensitive removal of adhesives or electrodes and the number of pressure ulcers caused by immobility or after medical devices for non-invasive pulmonary ventilation use increased. e number of contact irritations after detergents or disinfection has also increased. e wet wound healing method prevailed over the classic method, which was most used in 2020. e vacuum method was also used once.
Keywords:
skin injury, neonate, results of the survey, nursing and treatment
Mgr. Jaroslava Fendrychová, Ph.D., Katedra anesteziologie, resuscitace, intenzivní a perioperační péče, Národní centrum ošetřovatelství a nelékařských zdravotnických oborů, Brno
Úvod do problematiky Podle autorů zahraničních studií, kteří se zabývali výskytem poranění kůže novorozenců při jejich hospitalizaci ve zdravotnickém zařízení, byly nejčastějším typem poranění dekubity vzniklé v souvislosti s imobilitou
vlhkostí v plenkové oblasti nebo okolí stomií a na třetím místě extravazace/ infiltrace jako následek intravenózní aplikace roztoků či léků (Steen et al., 2020). K dalším poraněním kůže novorozenců docházelo v důsledku používání dráždivých mycích přípravků, nešetrného stržení náplastí nebo elektrod, nezajištění dítěte při polohování nebo oblékání do příliš těsných plenkových kalhotek a prádla. Identifikována byla i termální poranění od monitorovacích pomůcek (například pulzní oxymetrie nebo transiluminace).
jednotlivých typů poranění, jejich lokalizaci a tak dále. Výsledky byly publikovány v roce 2022 v časopisu Pediatrie pro praxi (Fendrychová, 2022) a prezentovány na konferencích pro nelékařské zdravotnické pracovníky v témže roce.
Metodika šetření
Cílem šetření v roce 2022 bylo opět zjistit četnost výskytu jednotlivých typů poranění, jejich lokalizaci, den výskytu po přijetí dítěte do zdravotnického zařízení, metodu léčby, délku hojení a případné komplikace a porovnat je s výsledky z roku 2020. Oslovena byla stejná zdravotnická zařízení jako v roce 2020, navíc se přihlásilo ještě jedno novorozenecké pracoviště.
a se zdravotnickými prostředky používanými k aplikaci neinvazivní plicní ventilace formou CPAP (continuous positive airway pressure) nebo HFNC (high flow nasal cannula) (King et al., 2014; Visscher et al, 2014). Na druhém místě bylo identifikováno poranění kůže spojené se zvýšenou
Cílem našeho prvního šetření, které proběhlo v roce 2020 v perinatologických centrech České republiky a ve dvou dalších zdravotnických zařízeních, která pod perinatologická centra nespadají, bylo zjistit, k jakým typům poranění kůže novorozenců dochází u nás, a určit četnost výskytu
Pro sběr dat byla vytvořena nová tabulka v programu MS Excel, do níž vybraní pracovníci zúčastněných zdravotnických zařízení zapisovali údaje o poškození kůže novorozenců. Sběru dat předcházelo setkání sester zabývajících se hojením ran, zúčastněných pracovišť, které z důvodu nepříznivé epidemiologické situace proběhlo online. Přihlášeným účastníkům byla představena nová tabulka pro sběr dat, která obsahovala jednotlivé buňky pro pohlaví, porodní hmotnost
15 téma hojení ran
Recenzovaný článek
Hodnocení výskytu poranění kůže u novorozenců nevede pouze k získání informací o četnosti, ale také k lepšímu rozpoznávání jednotlivých typů poranění a ke zpřesňování metodiky šetření.
Novorozenecká kůže, prevence jejího poranění a některé kazuistiky
Souhrn:
Klíčová slova:
Summary:
Novorozenecká kůže je zcela odlišná od kůže dospělého člověka, adaptuje se na nové prostředí a podněty. Rozlišujeme kůži donošeného a kůži nezralého novorozence, která je ještě specifičtější a vyžaduje jinou a ještě citlivější péči. Novorozenec se adaptuje několik dní po porodu i v dalším období na podněty, se kterými přichází jeho kůže do styku a ovlivňuje její schopnost přizpůsobení. Dítě v tomto období vyžaduje individuální přístup, šetrnou manipulaci a polohování, oblečení velmi jemných a vzdušných struktur a používání vhodných přípravků v co nejmenší míře z důvodu velké absorpce novorozenecké kůže. Prevence poranění zvláště zdravotnickou technikou, ať při vybavování plodu, nebo při pobytu dítěte v nemocnici z důvodu nedonošenosti a nezralosti, je tím nejdůležitějším, na co se zaměřujeme. K prevenci používáme speciální pomůcky a prostředky vhodné pro novorozence a individualizovaný přístup k dítěti a situacím, které mohou nastat. Kazuistiky přibližují poranění a jejich léčbu. Prevence je v naší práci na prvním místě, proto poranění u takto malých dětí ubývá, což je naším hlavním cílem. novorozenec, prevence, poranění, léčba
Neonatal skin, prevention of its injuries and some case reports
Newborn skin is completely different from adult skin, it adapts to new environments and stimuli. We distinguish between the skin of a full-term newborn and the skin of an immature newborn, which is even more specific and requires different and even more sensitive care. A few days after birth and in the following period, a newborn adapts to the stimuli with which his/her skin comes into contact and affects its ability to adapt. During this period, the child requires an individual approach, gentle handling and positioning, clothing with very fine and airy structures and the use of suitable products to the lowest extent possible due to the high absorption of the newborn skin. e prevention of injuries, especially with medical technology, whether during handling of the fetus or during the stay of the child in the hospital due to prematurity and immaturity, is the most important thing we focus on. For prevention, we use special devices and equipment suitable for newborns and an individualized approach to the child and the situations that may occur. e case reports provide an overview of injuries, their treatment and prevention. Prevention is on the first place in our work, which leads to the reduction of injuries in such young children, which is our main goal.
Keywords:
newborn, prevention, injury, treatment
Ilona Antoníčková, Neonatologické oddělení, FN Olomouc Anna Žáková, Neonatologické oddělení, JIRP FN Olomouc, konzultantka na rány u novorozenců
Úvod
Kůže jako rozhraní mezi zevním a vnitřním prostředím organizmu plní především funkci bariéry. Správnou péčí o kůži lze zvýšit její obranyschopnost, a předcházet tak vzniku mnohých onemocnění. Kůže dětí se od dospělých liší morfologicky i funkčně.
Kůže donošeného novorozence je silná přibližně 1,2 mm, u dospělého člověka kolem 2,1 mm, v podkoží je výrazně více vody, ale méně tuku. Množství podkožního tuku stoupá s věkem. Potní žlázy jsou funkční od 3. dne života novorozence, mazové žlázy jsou přechodně aktivní těsně po porodu a následně až od 4. měsíce života kojence.
Po narození je kůže novorozence pokryta mázkem (vernix caseosa), který tvoří takzvaný ochranný film. Mázek působí izolačně, antimikrobiálně a má nezastupitelnou hydratační funkci.
Podílí se na acidifikaci kůže. Pomocí acidifikace dochází ke snížení pH kůže novorozence, které zajišťuje vyšší ochranu před infekcí. Mázek podporuje rychlejší hojení kůže po porodu novorozence. Světová zdravotnická organizace (WHO) doporučují mázek neumývat, ani nestírat z pokožky. Největší část mázku se vstřebá do 24 hodin, zbývající do 5 dnů po porodu, jen v kožních záhybech to může být i později.
Mázek obsahuje vodu, bílkoviny, tuky, lanugo a odloupané buňky peridermu. Působí jako hydrofobní bariéra, a chrání tak kůži před macerací plodovou vodou, pomáhá vývoji kůže a brání ztrátě tekutin a elektrolytů.
Kůže nedonošených novorozenců neobsahuje dostatečné množství keratinu, což způsobuje zvýšené ztráty tělesného tepla i tělesné vody, především během 1. týdne jejich života. Nedonošení novorozenci také mají velmi tenkou svrchní část pokožky tvořící ochrannou vrstvu. Tenká vrstva pokožky je pak snadno prostupná pro vodu i teplo, a tím dochází k vyšším ztrátám tepla než u zralých, donošených novorozenců. Jedním z dalších obtíží je nedostatek podkožního tuku, který dostatečně nezakryje drobné
cévní kapiláry, a tak dítě často působí doslova průhledně. Kůže nezralého novorozence je oproti kůži donošeného o 40 % tenčí, kožní kolagen je nezralý a stejně tak i elastin, který má významný vliv na pružnost a odolnost kůže. Výsledkem je, že nezralý novorozenec je velmi náchylný pro vznik kožních defektů, a řadíme ho tak do kategorie velmi rizikových pacientů. Kůže nedonošeného dítěte je velmi jemná a citlivá, zvláště pak na dezinfekční prostředky a některé zdravotnické materiály.
Péče o kůži V Národním ošetřovatelském postupu (MZ ČR, 2020) – Péče o kůži novorozence jsou uvedeny zásadní postupy péče. Vědecký vývoj a ověřování postupů se stále vyvíjí a některé kroky se mění, používané materiály a přípravky se ověřují a jejich používání se zakazují, nebo doporučují.
Vliv na péči o kůži novorozence nemají jen zdravotníci, ale především rodiče, kteří sledují moderní trendy v péči u nás i ve světě, a naše vzájemná interakce vede ke kvalitní péči o jejich děti.
Péče o kůži donošeného novorozence je zaměřena na koupel, otírání
18 florence 3/23
téma hojení ran fota: archiv autorek
Stomií život nekončí
Pacientská organizace České ILCO, z. s., usnadňuje stomikům a jejich blízkým nelehkou chvílí, kdy je pacientům vytvořena stomie. Učí je žít s vývodem a pomáhá jim radou a osobními zkušenostmi. „Nebýt na to sami“ je důležitým mottem organizace.
Co je pacientská organizace České ILCO, z. s.?
Pomáháme řešit zdravotní, sociální a psychické problémy, které jsou spojeny s návratem stomika do běžného života. Naším cílem je také veřejnosti ukázat, že stomie není tabu a že za vývod se není potřeba stydět. Za naši práci jsme v lednu 2023 dostali prestižní ocenění Neziskovka roku v kategorii Malá neziskovka. Za tuto cenu jsme moc rádi a motivuje nás k další práci.
Jak pomáháte novým stomikům?
V našich řadách máme kvalitní dobrovolníky, kteří jsou ochotni přijít za stomikem do nemocnice nebo domů a zodpovědět otázky, které ho zajímají či trápí. Novinkou je dobrovolnictví online formou, kterou využívají především mladí lidé.
Zajímavostí na našem dobrovolnictví je to, že všichni naši dobrovolníci jsou sami stomici a sami řešili různá onemocnění, která vedla k vyvedení stomie. Je to veliký benefit, protože nového stomika nejvíce uklidní to, když vidí naživo člověka, který sice pod oblečením skrývá stomický sáček, ale jinak normálně žije, pracuje, sportuje a raduje se ze života. Nikdo totiž neví tak dobře jako my, stomici, co je třeba pro to, abychom se cítili dobře, a jak řešit každodenní problémy. Prošli jsme si tím samým a už víme, že stomií život nekončí.
Jak funguje vaše dobrovolnictví?
Na našich webových stránkách najdete kontakty na naše koordinátory dobrovolníků. Ti následně předají informaci dobrovolníkovi a ten se spojí s pacientem. Také nás může kontaktovat přímo stomická sestřička, která má pacienta v péči.
Jak spolupracujete se stomickými sestřičkami?
Stomické sestřičky jsou nepostradatelným článkem jak pro nás, tak pro stomiky. Nejenže jim dodáváme propagační a edukační materiály pro
stomiky, ale poskytujeme jim kontakty na dobrovolníky. Benefitem pro sestřičky je časová úspora, neboť dobrovolníci často stomikovi zodpoví otázky, na které se sestřičky nestihl nebo i obával zeptat.
Co když dobrovolník na pomoc nestačí?
Pokud tato situace nastane a dobrovolník nemůže pomoci například z důvodu, že psychický stav pacienta vyžaduje odbornou pomoc, máme k dispozici ILCO Linku. Ta je v provozu jednou za 14 dní a je určena pro stomiky nebo jejich blízké. Garantem ILCO Linky je doc. PhDr. Dr.phil. Laura Janáčková, CSc., která poskytuje psychologickou podporu a poradí, jak se vyrovnat se strachy, obavami, úzkostí či depresí. Pomáhá například také řešit partnerské vztahy, intimní a sexuální problémy a hledá individuální cestu k pozitivnímu myšlení a vnímání. Stačí si jen zarezervovat termín prostřednictvím dotazníku na našich webových stránkách. ILCO Linka je provozována v rámci našeho projektu „Ano, my můžeme!“ financovaného z Fondů EHP.
Vše o anketě a jak hlasovat naleznete zde: www.ilco.cz/aktivity-a-projekty/ moje-stomicka-sestra/

Jaká je v dnešní době péče o stomiky?
Péče o stomické pacienty je kvalitní. Na českém trhu najdeme osm výrobců stomických pomůcek. Výběr je opravdu široký. Každý stomik by měl mít svou stomickou sestřičku. Její práce nespočívá pouze v dobré edukaci a zvolení vhodného místa pro stomii. Její obličej stomik vidí hned po operaci a sestra mu pomáhá zvyknout si na vývod. Učí ho o stomii správně pečovat, ošetřovat ji a pomáhá s výběrem vhodných pomůcek i to, jak je používat. Práce stomické sestry je často psychicky, fyzicky a časově náročná. Proto již léta na den sester spouštíme anketu Moje stomická sestra roku.
V čem spočívá tato anketa?
Cílem je ocenit práci, empatii a pochopení, které mají stomické sestřičky pro každého stomika. V této anketě nejde o věk ani o fyzickou krásu, ale o krásu srdce, laskavost a lidskost. Naším záměrem je vyzdvihnout náročnou práci, profesionalitu, chování a empatii stomických sestřiček nejen ke stomikům, ale i k jejich blízkým, a také jim touto cestou poděkovat. Všechny nominované sestřičky obdrží certifikát a ta s největším počtem hlasů diplom a milé překvapení.
21
téma hojení ran
Jana Kurková, koordinátor, administrátor České ILCO, z. s.
Chemická nekróza u extrémně nezralého novorozence – kazuistika
Souhrn:
Klíčová slova:
Summary:
Kůže předčasně narozených novorozenců je nedostatečně vyvinutá, aby zajistila účinnou bariéru proti působení chemických látek, které jsou obsaženy v dezinfekčních roztocích. Stále neexistuje dostatečně účinné a zároveň bezpečné antiseptikum pro použití u extrémně nezralých novorozenců. Většina komplikací po použití antiseptik se projevuje přechodnou erytematózní vyrážkou, ojediněle ale dochází i k závažnější formě poškození kůže. Kazuistika popisuje vývoj poškození kůže, ke kterému došlo po aplikaci dezinfekčního roztoku do okolí pupečního pahýlu před kanylací umbilikálních cév u novorozence narozeného ve 25. týdnu těhotenství. Uveden je postup při výběru a aplikaci materiálů vlhkého hojení ran k ošetření vzniklé nekrózy s ohledem na stadia hojení, místo vzniku a frekvenci převazů. nekróza, vlhké hojení ran, nezralý novorozenec
Keywords:
Chemical necrosis of extremely premature newborn – case report e skin of premature newborns is not developed sufficiently to serve as an effective barrier against the effect of chemicals contained in disinfectants. ere is still no adequately efficient and safe disinfectant for use in extremely premature newborns. Most complications after the use of antiseptics are manifested by a transient erythematous rash, however, occasionally a more severe form of skin damage occur. is case report describes the development of skin damage after application of an antiseptic solution to the umbilical stump before cannulation of the umbilical vessels in a neonate born at 25 weeks of gestation. Interventions of selection and application of materials for moist wound healing to treat necrosis are presented, with respect to the healing stage, site of origin, and frequency of dressings. necrosis, wet wound healing, immature newborn



Všeobecné fakultní nemocnice v Praze
Pacientkou je extrémně nezralá, eutrofická dívka porozena císařským řezem ve 25. týdnu těhotenství, vážící 685 gramů. Zajištění cévních vstupů bylo provedeno kanylací umbilikálních cév (arterie a vény). K dezinfekci pupečního pahýlu a okolí před výkonem byl použit roztok Octenisept, který obsahuje ve 100 g roztoku: octenidini-dihydrochloridum 0,1 g, phenoxyethanolum 2,0 g, dále pomocné látky: kokamidopropylbetain, natrium-glukonát, glycerol 85 %, chlorid sodný, roztok hydroxidu sodného 100 g/l a čištěnou vodu.
Po výkonu byly znatelné změny na kůži, porucha prokrvení v okolí pupečního pahýlu ve středním mezogastriu velikosti přibližně 1,5 × 2 cm (obr. 1).

Místo bylo šetrně opláchnuto sterilní vodou k odstranění předpokládaných zbytků dezinfekčního roztoku. Poškození kůže bylo vyhodnoceno jako popálenina III. stupně. Výběr materiálů k ošetření defektu byl ovlivněn požadavkem, aby mohlo být miminko co nejdříve uloženo do pronační polohy, která má u nedonošených dětí, stejně jako u dospělých, příznivý vliv na provzdušnění plic. Vzhledem k této poloze a k faktu, že rána se nachází
v plenkové oblasti, byl k prvnímu ošetření zvolen materiál Urgotul (obr. 2), neadhezivní lipidokoloidní mřížka, která byla fixována polyuretanovou pěnou se silikonovou adhezí Mepilex Lite. Tato kombinace nám zajistila ochranu rány před mechanickým působením na ránu, tlakem, třením polohovacích pomůcek a také před chemickým působením moči a stolice. Převazy se prováděly jednou za 24 hodin. U holčičky jsme sledovali projevy diskomfortu a bolesti, preventivně byl proto podáván paracetamol
intravenózně, holčička hezky reagovala na nefarmakologické tišení bolesti podáním 0,2 ml roztoku 25% sacharózy perorálně před převazem. V průběhu následujících dní došlo k demarkaci poškozené tkáně. Druhý den byla rána hodnocena jako bílá, nekrotická, v oblasti kožního valu pupečního pahýlu a oblasti pod pupkem 1 × 2 cm s neznámou hloubkou poškození (obr. 3). Čtvrtý den se objevila čtyři malá tmavší nekrotická ložiska v okraji rány (obr. 4). Zvolili jsme změnu terapeutického krytí,
22 florence 3/23
Bc. Pavla Neradová, všeobecná dětská sestra, konzultantka hojení ran, JIRP neonatologického oddělení
téma hojení ran fota: archiv VFN v Praze 1 2 3 4
gynekologie téma
Sexuálně přenosná onemocnění a riziko mimoděložní gravidity
Zpráva Světové zdravotnické organizace uvádí, že sexuálně přenosná onemocnění jsou na vzestupu. Onemocnění vystavují ženu akutním i dlouhodobým rizikům pro její reprodukční zdraví, proto by strategie cílené na zachycení asymptomatických a časných infekcí měly být ve zdravotním systému prioritou.
Dle zprávy Světové zdravotnické organizace (WHO) z roku 2022 jsou sexuálně přenosná onemocnění na vzestupu. Ve Spojených státech se to týká syfilidy, nárůstu případů vrozené syfilidy, infekcí chlamydiemi (Cht –chlamydie trachomatis) a kapavky (NG – neisseria gonorrhoae). Důvodem mohou být i snížená preventivní a screeningová opatření během pandemie covidu-19. Celosvětově zůstává závažným problémem antimikrobiální rezistence bakterií NG a Mycoplasma genitalium (WHO, 2022).
Pánevní zánětlivé onemocnění (PID

– pelvic inflamatory disease) je způsobeno převážně patogeny bakteriální vaginózy, Cht nebo NG. Pokud je onemocnění způsobeno NG, bývá klinický průběh mnohem komplikovanější než infekce chlamydiová.
Neisseria gonorrhoae
Neisseria gonorrhoae je v poslední dekádě druhé nejčastější sexuálně přenosné bakteriální onemocnění.
Jedná se o gramnegativní aerobní bakterii s afinitou k cylindrickému a přechodnému epitelu urogenitálu, rekta, orofaryngu a faryngu. Může probíhat asymptomaticky a vyústit v závažné komplikace, jako je PID, mimoděložní těhotenství (GEU – graviditas extrauterina), infertilita nebo gonokoková sepse. V těhotenství může být NG zodpovědná za předčasný
odtok plodové vody, předčasný porod a postpartální endometritózu. U novorozenců jsou popsány případy neonatální pneumonie i konjunktivitidy. Neonatální NG může vzácně diseminovat a způsobit i bakteriální meningitidu, endokarditidu nebo myokarditidu (Kirkcaldy et al., 2019).
Chlamydia trachomatis






















Nejčastější bakteriální, sexuálně přenosné onemocnění postihující ženy i muže je Cht sérotyp D-K. Tato obligatorní gramnegativní bakterie má tropizmus k cylindrickému epitelu genitálu, respiračního systému a konjunktivy, vyskytuje se v makrofázích a poškozuje kloubní výstelku i endotel. V porovnání s jinými mikroorganizmy má unikátním životní cyklus. Elementární tělíska jsou vysoce

24
MUDr. Jana Racková, Gynekologicko-porodnická klinika, 1. LF UK, FN Bulovka, Praha
foto: Freepik
Výživa u vícečetného těhotenství
Výživa během těhotenství je jedním z nejdůležitějších faktorů, které jsou nezbytné jak pro udržení zdraví matky, tak pro vývoj plodu, který je na přísunu živin od matky závislý.
Marieta Baliková,
Motol
Vzhledem k tomu, že vícečetné těhotenství s sebou nese mnohem větší rizika pro matku i pro vyvíjející se plody, je zde správná výživa zcela zásadní. V současnosti je dané téma stále více aktuální z důvodu nárůstu frekvence výskytu vícečetného těhotenství v souvislosti s léčbou neplodnosti. Při vícečetném těhotenství se v děloze současně vyvíjí a poté rodí více plodů. Podle počtu vyvíjejících se plodů jde o dvojčata – gemini, trojčata – trigemini, čtyřčata – quadremini a tak dále. Vícečetné těhotenství vzniká oplozením jednoho nebo více vajíček jednou nebo více spermiemi.
U dvojčat dále rozlišujeme dvojčata jednovaječná a dvouvaječná. Jednovaječná dvojčata se vyvíjí z jednoho oplozeného oocytu, mají vždy stejné pohlaví a jsou si velmi podobná, zatímco u dvouvaječných dvojčat se každý plod vyvíjí z jiného oocytu a mohou být stejného i různého pohlaví. U trojčetného a vícečetného těhotenství se může jednat o jednovaječná, dvouvaječná i vícevaječná trojčata, čtyřčata a tak dále nebo o jejich kombinaci.
Adaptace matky na vícečetné těhotenství je spojena se zvýšením produkce steroidních a bílkovinných hormonů. Sekrece progesteronu a lidského placentárního laktogenu je u vícečetného těhotenství větší než u jednočetného těhotenství. Tyto hormony ovlivňují metabolizmus glukózy, a tím jsou dávány do souvislosti s větším rizikem inzulinové rezistence a vzniku gestačního diabetu. Dále bylo prokázáno, že u ženy čekající dvojčata dochází ke zvýšení počtu erytrocytů o 25 % a ke zvýšení objemu krve o 50–70 %, s čímž je spojeno následné snížení koncentrace hemoglobinu, albuminu a vitaminů rozpustných ve vodě a naopak zvýšení koncentrace vitaminů rozpustných v tucích, triglyceridů, cholesterolu a volných mastných kyselin. Pokles hladiny albuminu v séru pak vede k hromadění extracelulární tekutiny. Placenta je hlavní místo produkce několika hormonů, které regulují růst plodu a rozvoj
mateřských podpůrných tkání a slouží jako přenašeč, prostřednictvím něhož jsou vyměňovány živiny, kyslík a odpadní látky. Jakékoli poškození nebo nedostatečnost placenty ohrožuje schopnost vyživovat plod. Jestliže nastane zmenšení velikosti placenty a snížení počtu placentárních buněk pod 15–20 % normy, dojde k selhání nitroděložního růstu.
Energetický příjem Vícečetné těhotenství představuje stav zvýšené nutriční potřeby, což má za následek vyšší čerpání živin od matky a zrychlenou spotřebu nutričních rezerv. V souvislosti s vyšším bazálním energetickým výdejem z důvodu nárůstu práce srdce, plic a metabolizmu plodu a dělohy se adekvátně mění požadavky na energetický příjem matky. Pro zajištění dostatečné energetické potřeby je doporučováno ženám čekajícím dvojčata přijímat o 150 kcal více než ženám s jednočetným těhotenstvím, což znamená, že by nastávající maminky měly navýšit svůj denní energetický příjem asi o 450 kcal. Abychom dosáhli daného energetického příjmu, je vhodné se řídit určitými pravidly. Evropská dietetická asociace navrhuje ženám s normální tělesnou hmotností jíst denně 3 porce mléka či mléčných výrobků, 3 porce masa, drůbeže, ryb či vajec, 3 porce zeleniny, 2 porce ovoce a 6 porcí obilovin, pečiva, rýže či těstovin.
Nedostatečný a nadměrný příjem bílkovin Je doporučeno u jednočetného těhotenství navýšit příjem bílkovin o 10 g za den a u dvoučetného těhotenství o 20 g za den, což představuje přibližně 70–80 g bílkovin za den. Při nízkém příjmu bílkovin potravou dochází k negativní dusíkové bilanci a k následnému zpomalení růstu, snížení koncentrace krevních bílkovin, snížení odolnosti k infekcím, zhoršenému hojení ran, vzniku edémů, anemii, poruchám tělesného a duševního vývoje, narušení enzymatických a metabolických procesů a nedostatečné syntéze glutathionu, který je významný pro detoxikační procesy. V těhotenství vede zejména k hypoproteinemii, vzniku otoků, nižší hmotnosti
placenty a úzce koreluje s porodní délkou a hmotností novorozenců.
Nadměrný přísun bílkovin zatěžuje játra a ledviny a současně u bílkovin živočišného původu vede ke zvýšenému příjmu skrytých tuků.
Nedostatečný a nadměrný příjem tuků
Vhodný poměr příjmu nasycených, mononenasycených a polynenasycených mastných kyselin je 1 : 1,4 : 0,6. Velký důraz je u vícečetného těhotenství kladen na zvýšený přísun esenciálních mastných kyselin – kyseliny linolové a alfa-linolenové, a to nejméně 4 % z celkového přísunu energie. Následkem nedostatečného příjmu tuků, především esenciálních mastných kyselin, může dojít k poškození neurologického a zrakového vývoje dětí. Nedostatek těchto kyselin také zkracuje dobu těhotenství a snižuje porodní hmotnost novorozenců. Nadměrný příjem tuků je zdrojem nevyužité energie, vede ke zvýšenému ukládání tuku v těle a ke vzniku obezity. Zvýšená konzumace tuků s obsahem převážně nasycených mastných kyselin zvyšuje cholesterolemii. Hladinu cholesterolu také ovlivňují transnenasycené mastné kyseliny, které vznikají při ztužování rostlinných tuků a v trávicím traktu přežvýkavců enzymatickou hydrogenací a zvyšují hladinu LDL cholesterolu v plazmě a snižují hladinu HDL lipoproteinů.
Nedostatečný a nadměrný příjem sacharidů
U matek čekajících dvojčata se objevují výrazně nižší koncentrace glukózy a inzulinu v séru a vyšší plazmatické koncentrace β-hydroxybutyrátu ve srovnání s jednočetným těhotenstvím. To naznačuje, že dochází k rychlejšímu vyčerpání zásob glykogenu a uloženého tuku. Pro lepší kontrolu glykemie je tedy doporučováno zastoupení sacharidů ve stravě do 40 % z celkového energetického příjmu, což představuje pro ženu s normální tělesnou hmotností před koncepcí asi 350 g sacharidů.
Nedostatek sacharidů ve stravě vede k poklesu pozornosti a snížení tělesného a duševního výkonu. Při výrazném poklesu hladiny glukózy
27
Mgr.
nutriční terapeutka FN
téma gynekologie
Souhrn:
Modré, nebo růžové embryo?
Etika v asistované reprodukci
Klíčová slova:
Summary:
Keywords:
Text reflektuje skutečnost, že preimplantační genetická diagnostika poskytuje naději na zdravé dítě i takovým párům, u kterých více pokusů o zdravého potomka selhalo. V rámci tohoto vyšetření embryí se však dozvídáme také informaci o pohlaví. Tento fakt by neměl být zneužíván k realizaci přání o narození chlapce, nebo děvčete. Nechtěná, přestože zcela zdravá embrya jsou totiž likvidována. etika, genetická diagnostika, pohlaví
Blue or pink embryo? Ethics in assisted reproduction

e manuscript reflects the fact that pre-implantation genetic diagnosis provides hope for a healthy child even for couples who have failed several times to have a healthy descendant. However, as part of this examination of the embryos, we also learn information about the sex. is fact should not be abused to realize the wish for the birth of a boy or a girl. Although completely healthy, unwanted embryos are disposed. ethics, genetic diagnosis, gender
Již ze Starého zákona známe příběh Mojžíše ukrytého u řeky. Proč tam byl schovaný? Matka se jej snažila zachránit před hrozbou smrti. Král chtěl totiž zabít všechny malé chlapce. Otázka pohlaví dítěte v nás zkrátka rezonovala odpradávna.
V ráji díky dceři
Notoricky známý je společenský status otce v muslimských zemích.
Čím větší počet chlapců dokázal otec zplodit, tím se jeví v rámci společnosti jako úspěšnější. Syn disponuje vyšším kreditem než dcera, protože on je pokračovatelem rodu. Potomek mužského pohlaví má rodinu stmelovat, dohlížet na ni. Mezi jeho další povinnosti patří zajistit rodiče ve stáří a pečovat o mladší sourozence. Ovšem muslimská tradice doporučuje v rodině také dceru, a to proto, že otec dcery má lepší šanci dostat se po smrti do ráje. Zavedení této tradice si pravděpodobně kladlo za cíl eliminovat neonacitidy (Nešporová, 2005). Na tomto příkladu lze registrovat známky dnes populárního trendu, jenž je světově známý pod názvem family balancing.
V dnešní době páry přistupují k několika způsobům, jak si vybrat preferované pohlaví. Z lékařského i lidského hlediska je bezesporu nejinvazivnějším zásahem pohlavně selektivní
potrat, kdy se těhotenství uměle přeruší po zjištění, že plod není nositelem preferovaného pohlaví. Žena absolvující tento zákrok je bezesporu vystavena psychické zátěži a zdravotnímu riziku. Nejméně invazivní je pak inovativní metoda prostřednictvím pohlavně selektivní inseminace, ale zde stále dochází k nepřesnostem. Nelze ji považovat za spolehlivou. Nejpřesnější a velmi často využívanou metodou je preimplantační genetika v rámci asistované reprodukce. Tato metoda vzbudila nejen naděje, ale také vážné morální, sociální a právní obavy (Kilani, 2004).
Naděje pro páry, u jejichž potomka XY nebo XX hrozí genetická vada?
Preimplantační genetická diagnostika slouží pro diagnostiku monogenních chorob a strukturních chromozomových abnormit. Indikací k tomuto diagnostickému kroku je vyšší věk matky, respektive obou rodičů,
potratovost v gynekologické anamnéze ženy nebo také dědičná choroba v rodinné anamnéze.
Preimplantační genetická diagnostika přinesla šanci na zdravé dítě například párům, u kterých klasická asistovaná reprodukce selhala. Embrya, jež nejsou geneticky v pořádku, se často ani neuhnízdí, jiná se zase zastaví ve vývoji v raných fázích. Ve specifických případech je ale chromozomální vada slučitelná s dalším vývojem plodu. Narodit se může třeba dítě s Downovým syndromem, známým také jako trizomie 21. Pokud je problém odhalen na screeningu, rodiče bývají postaveni před velmi závažné rozhodnutí. Diagnostika vyšetřující embrya před transferem do dělohy ženy tyto problematické jevy eliminuje.
Metodou lze vyšetřit všech 23 párů chromozomů; dozvídáme se tedy i informaci o pohlaví, která by měla být jen jakýmsi vedlejším produktem v kontextu celkového zdraví embrya.
29
Mgr. Anna De Bayas Sanchez1,2 , Bc. Michaela Kalivodová1 , Helena Bakar1 , 1 Mediversvm s. r. o., Medistella, Praha
2 Zdravotně sociální fakulta, Jihočeská univerzita v Českých Budějovicích
foto: Freepik téma gynekologie
Ošetrovateľská starostlivosť u pacienta s dekubitom v domácom prostredí
Súhrn:
Kľúčové slová:
Summary:
Keywords:
Hlavným cieľom článku bolo popísať problematiku ošetrovateľskej starostlivosti o pacienta s dekubitom v domácom prostredí.
dekubit, ADOS služba, domáca starostlivosť, ošetrovanie, prevencia
Nursing care for a patient with pressure ulcers in the home environment e main aim of this article was to describe the nursing care of a patient with decubitus in the home environment. pressure ulcer, reception centre with nursing care, home care, nursing, prevention
PhDr. Silvia Danková, PhD., dipl. s., Ústav ošetrovateľstva, LF UPJŠ, Košice, Slovenská republika
PhDr. Martina Jadrníčková, MPH, II. Interná klinika, Univerzitná nemocnica L. Pasteura Košice, Slovenská republika
Úvod
S pribúdaním imobilných pacientov a ľudí s vyšším vekom sa do popredia dostáva problematika chronických rán a dekubitov v nemocničných zariadeniach aj v domácom prostredí. U týchto pacientov pribúdajú fyzické a psychické obmedzenia, problémy s príjmom potravy (podvýživa), nedostatkom príjmu tekutín – následne k zhoršovaniu stavu rán a nehojacim procesom. Dekubity vznikajú aj nedostatočným ošetrovaním už vznikajúceho dekubitu, či neskorým začatím ošetrovania.
Nezastupiteľnú
Domáca ošetrovateľská starostlivosť je celosvetovým trendom, ktorý tvorí neoddeliteľnú súčasť moderného systému zdravotnej starostlivosti aj na Slovensku. V domácej ošetrovateľskej starostlivosti je sestra dôležitým pomocníkom pre rodinu pri riešení problémov vyplývajúcich z opatrení týkajúcich sa ošetrovateľskej starostlivosti o postihnutého člena rodiny. Po príchode do domácnosti sestra zmapuje celkovú situáciu v rodine. Zameriava sa na vzťahy v rodine, počet rodinných príslušníkov, finančné zabezpečenie a celkovú ekonomickú situáciu, úroveň hygieny a zdravotného povedomia
rodinných príslušníkov a ich úroveň mentality a schopnosti spolupracovať. Na základe týchto poznatkov je potom schopná spolu s rodinou, pacientom, prípadne inými osobami zainteresovanými do starostlivosti vytvoriť funkčný komplexný ošetrovateľský plán pre pacienta, pričom sa priamo podieľa na riešení problémov súvisiacich so stavom pacienta a jeho rodinou. Sestry v Azylovom dome s ošetrovateľskou službou (ADOS) poskytujú pacientom a ich rodinám poradenstvo nielen v oblasti zdravotnej (nárok na predpis rehabilitačných pomôcok, absorpčných pomôcok pri inkontinencii, nárok na návštevu lekára do bytu pacienta, prevoz na vyšetrenia), ale aj v oblasti sociálnej (nárok pacienta na opatrovateľskú službu ak ju nemôžu zabezpečiť rodinní príslušníci, alebo nárok rodiny na opatrovateľský príspevok). Ťažisko ošetrovateľskej starostlivosti sestry
o samotný dekubit, ale aj o celkový zdravotný stav pacientky;
→ posúdiť kompletný zdravotný stav pacientky dôsledným zberom anamnézy od pacientky a jej rodiny a následne zhodnotiť riziko vzniku nových dekubitov s využitím vhodných škál a stupníc;
→ popísať a zdokumentovať stav prítomného dekubitu, ako aj samotný priebeh ošetrovania a hojenia dekubitu;
→ podporiť psychický a fyzický stav pacientky vhodnou edukáciou o dodržiavaní preventívnych opatrení a tým úspešne docieliť zlepšenie kvality života u nej.
Výber metodiky
Priame a nepriame pozorovanie pacientky. Informácie sme získavali rozhovorom s pacientkou a jej dcérou, ktorá žije s ňou v spoločnej domácnosti. Použili sme obsahovú analýzu zdravotnej dokumentácie, zhotovenie a použitie fotodokumentácie. Fotodokumentáciu sme získali na základe informovaného súhlasu pacientky, pričom bola zachovaná anonymita u pacientky. Starostlivosť o pacientku bola realizovaná v SADOS s. r. o., Michalovce.
v ADOS spočíva v edukácii. Sestra edukuje nielen pacienta, ale aj rodinu alebo podporné osoby o hygiene, výžive, pitnom režime, úprave lôžka, polohovaní a o zabezpečení antidekubitárnych pomôcok.
Cieľ práce
Popísať a zdokumentovať ošetrovateľskú starostlivosť o pacienta s dekubitom v domácom prostredí.
Čiastkové ciele:
→ poukázať na dôležitosť ošetrovateľskej starostlivosti o pacientku so vzniknutým dekubitom, kde je potrebná starostlivosť nie len
Kazuistika
Pacientka, 74 let, s diabetes mellitus prijatá na interné oddelenie. Dôvod hospitalizácie – ťažkosti pri dýchaní, celková slabosť. Pri prijatí spolupracovala, na otázky primerane odpovedala. Orientovaná v čase a priestore. Na urgentný príjem prišla v sprievode dcéry.
U pacientky boli realizované vyšetrenia. EKG vyšetrenie, vykonaný Ag test – negatívny, fyziologické funkcie: krvný tlak: 165/95 mmHg –hypertenzia, pulz: 97/min – tachykardia, dýchanie: 26 dyspnoe, telesná teplota: 36,2 – afebrilná. Pacientke bola zavedená periférna venózna
32 florence 3/23
Recenzovaný článek
recenzovaný článek
úlohu pri samotnej ošetrovateľskej starostlivosti o dekubity zohráva pacient, jeho prístup k liečbe a rodina pacienta.
Simulace ve výuce porodních asistentek
Souhrn:
Klíčová slova:
Summary:
Keywords:
Simulace je stále častější a mezinárodně uznávaná metoda výuky v porodní asistenci. Staví studentky uměle do reálných situací. Studentky se tím učí efektivně reagovat a získávat praktické dovednosti, aniž by poškodily pacientky. Hlavním cílem výzkumu bylo zjistit, zda se metoda simulací využívá také ve výuce porodních asistentek v Čechách a v Rakousku. simulační trénink, porodní asistence, vzdělávání, Rakousko, Česká republika
Simulation in midwifery education
Simulation is an increasingly common and internationally recognized teaching method in midwifery. Midwifery students are artificially placed in real-life situations. e students learn to respond effectively and acquire practical skills without harming patients. e main goal of the research was to find out whether the simulation method is also used in the teaching of midwives in the Czech Republic and Austria. simulation training, midwifery, education, Austria, Czech Republic
Úvod
Simulace nacházejí stále větší využití při výuce porodních asistentek (Martins et al., 2018). Studentky porodní asistence při nich mají možnost simulovat nejrůznější klinické situace (nejčastěji na modelech), a učit se tím prakticky a efektivně zvládat svou profesi v bezpečném prostředí, aniž by při tom ohrožovaly pacientky.
Simulační výuka je praktická a eticky korektní metoda výuky (Cooper et al., 2012). Umožňuje studentkám porodní asistence propojit získané teoretické vědomosti s praxí (Abas et al., 2016). Připravuje studentky porodní asistence na kritické situace, se kterými se mohou v praxi kdykoli setkat (Temesgen Worku et al., 2015).
Simulační výuka probíhá v bezpečném prostředí, ve kterém je v pořádku udělat chybu a poučit se z ní (Lathrop et al., 2007). Studentky díky simulační výuce nabývají sebevědomí, jsou celkově spokojenější a mají pocit většího bezpečí. Cítí se kompetentnější k tomu, aby v budoucnu zvládly
podobné reálné situace (Labrague et al., 2019). Získávají lepší rozhodovací schopnosti (Abukhousa et al., 2014). Simulační výukou se také zvyšuje bezpečí žen, které mají porodní asistentky v péči (Nestel et al., 2018), a snižují se celkové náklady ve zdravotnictví (World Health Organization, 2019). V mnoha zemích je simulační výuka považována za důležitou výukovou metodu v porodní asistenci a je uznávána na mezinárodní rovině (Loewenhardt et al., 2021). Zda se již simulační výuka také běžně využívá na českých a rakouských vysokých školách a univerzitách vzdělávajících porodní asistentky, nebylo možné z dostupných literárních zdrojů spolehlivě identifikovat. Proto byl na IMC FH Krems v Rakousku v rámci magisterského studia proveden výzkum na toto téma. Cílem bylo zjistit, zda se simulační výuka na vysokých školách a univerzitách vzdělávajících porodní asistentky v České a Rakouské republice využívá. Pokud by se využívala, tak v jaké míře, a jakým způsobem. Dalším cílem bylo zjistit, jaká témata se toho času v porodní asistenci na těchto vzdělávacích institucích simulují a zda se experti domnívají, že je simulační výuka v porodní asistenci na konkrétních institucích v daných zemích dostatečně zahrnuta, či nikoli.
Metodologie
Bylo provedeno průzkumné šetření formou expertních strukturovaných rozhovorů. Jako expertky v této oblasti byly vybrány vedoucí bakalářského oboru porodní asistence na jednotlivých vzdělávacích institucích, případně vyučující, jež se simulační výukou v bakalářském studiu porodní asistence na konkrétních institucích zabývají. Každá instituce směla být zastoupena pouze jednou expertkou. Celkem bylo rekrutováno 5 expertek z 8 vzdělávacích institucí v Rakousku a 8 expertek z 11 vzdělávacích institucí v České republice. Účast na průzkumu tímto byla 68 %. Expertní rozhovory probíhaly především online na platformě MS Teams za současného nahrávání na diktafon. Nahrávky byly následně transkribovány. Touto metodou byly sesbírány dva druhy dat. Kvalitativní data byla analyzována pomocí tříkrokové tematicko-analytické obsahové analýzy (dle Kaisera, 2014): nejprve byl textový materiál zredukován na analyticky relevantní obsah, dále byly k relevantním pasážím přidány doplňující a vysvětlující informace, a nakonec byly tyto relevantní pasáže rozřazeny do nejrůznějších kategorií, které vyplynuly ze samotného materiálu. Kvantitativní data byla analyzována statistickými metodami v MS Excel.
36 florence 3/23
Bc. Anežka Hanáková, MSc, Ústav pro péči o matku a dítě v Praze Claudia Oblasser, MA, PhD, IMC FH Krems, Krems an der Donau, Rakousko
Recenzovaný článek Graf 1 Počet hodin ve vzdělávacích institucích 900 800 700 600 500 400 300 200 100 0 Exp. 1Exp. 4Exp. IIExp. VIExp. 2Exp. 5Exp. IIIExp. VIIExp. 3Exp. IExp. VExp. IVExp. VIII vzdělávací instituce počet hodin 150 837,5 200 214 34 315 150 56 60 200 20 129 420 recenzovaný článek
Motivace k výkonu profese všeobecné sestry v intenzivní péči
Souhrn:
Klíčová slova:
Summary:
Téma motivace v ošetřovatelské profesi je aktuální zejména v důsledku zvyšujícího se personálního nedostatku na pozici všeobecná sestra. Nedostatek sester postihuje celou Českou republiku napříč všemi sektory, sestry častěji migrují a odcházejí z profese. Motivace a spokojenost hraje v profesi všeobecné sestry v intenzivní péči důležitou roli, ovlivňuje její pracovní výkon, který má přímý vliv na kvalitu poskytované ošetřovatelské péče. Text je rozdělen do dvou částí. Část teoretická se zabývá obecně motivací, pracovní motivací, specifiky práce a pracovní spokojeností všeobecné sestry v intenzivní péči. Praktická část mapuje motivaci a spokojenost všeobecných sester v intenzivní péči. intenzivní péče, motivace, motivační faktory, pracovní spokojenost, všeobecná sestra
Motivation to perform the profession of general nurse in intensive care
e topic of motivation in the nursing profession is currently topical, mainly due to the growing shortage of general nurses. e shortage of nurses affects the entire Czech Republic across all sectors; nurses are more likely migrate and leave the profession. Motivation and satisfaction play an important role in the profession of general nurse in intensive care as they affect work performance, which has a direct impact on the quality of nursing care provided. e manuscript is divided into two parts. e theoretical part deals with general motivation, work motivation, work specifics and job satisfaction of general nurses in intensive care. e practice part maps the motivation and satisfaction of general nurses in intensive care.
Keywords:
general nurse, intensive care, job satisfaction, motivation, motivational factors
Úvod
Ve zdravotnictví je motivace a spokojenost studována již od 30. let 20. století. V současné době se stále více zaměřuje pozornost na motivaci a pracovní spokojenost, protože je potřeba vytvořit takové prostředí, které by zabránilo fluktuaci zdravotnických pracovníků a problémům pramenícím z jejich nedostatku (Vévoda et al., 2013). Podle Ústavu zdravotnických informací a statistiky (ÚZIS) není situace v České republice uspokojující. Za rok 2020 bylo hlášeno celkem 82 572 všeobecných sester a porodních asistentek. To je o 1 125 sester méně než v roce 2010 (ÚZIS, 2020).
Zvýšená nestabilita a fluktuace sester z důvodů nízké pracovní spokojenosti přináší problémy pro celou společnost. Pro zdravotnické služby je to zejména snížená kvalita zdravotnické péče a finanční ztráty. Častý nábor sester je nevýhodný z důvodu času zaškolování, orientace a adaptace (Vévoda et al., 2013). Práce v ošetřovatelství je velmi náročná a může se stát zdrojem pracovní nespokojenosti, zatímco nadměrné pracovní vytížení může ovlivnit výkon zaměstnanců (Kaur et al., 2017).
Cílem práce bylo zjistit, jaká je motivace k výkonu profese všeobecných sester v intenzivní péči. Další cíle se pak zaměřují na pracovní spokojenost
všeobecných sester v intenzivní péči, vztah demografických charakteristik a spokojenosti sester a poslední cíl má za úkol zjistit, jak sestry hodnotí motivaci ze strany svého zaměstnavatele. Pokud se motivace sester nebude dostatečně podporovat a jejich práce bude podceňována, budou sestry i nadále opouštět jak svá pracoviště, tak zejména svou profesi.
Metodika výzkumného šetření Záměrný výběr se stanovenými kritérii tvořili respondenti z řad všeobecných sester pracujících v intenzivní péči. Konkrétně se jednalo o všeobecné sestry pracující v hlavním městě Praha, a to ve Fakultní nemocnici Královské Vinohrady, Všeobecné fakultní nemocnici v Praze, Fakultní omayerově nemocnici a ve Fakultní nemocnici Bulovka. Celkově bylo osloveno
1 200 sester z těchto nemocnic. Návratnost dotazníků činila 75,58 %, tedy celkově 907 dotazníků. Z důvodu špatného či neúplného vyplnění dotazníků bylo z dotazníkového šetření vyřazeno 54 dotazníků. Pro finální zpracování dat výzkumného šetření bylo použito 853 (71 %) odpovědí respondentů.
Dotazníkové šetření probíhalo v termínu od března do května roku 2021.
Metodika práce
Pro práci byla zvolena metoda kvantitativního výzkumu. Výzkum probíhal pomocí vytvořeného dotazníku. Tento dotazník obsahoval demografické otázky, standardizovaný dotazník McCloskey/Mueller Satisfaction
Scale (MMSS) a nestandardizovaný dotazník inspirovaný Mgr. Jiřím Vévodou. Tento nestandardizovaný dotazník je publikován v češtině a je volně přístupný v knize Motivace sester a pracovní spokojenost ve zdravotnictví. Sám autor zde uvádí, že by byl rád, kdyby i ostatní výzkumníci využili jeho dotazníku, jelikož by měl splňovat všechny metodologické náležitosti a měl by se opakovat v čase (Vévoda et al., 2013).
Souhlas s možností využití standardizovaného dotazníku MMSS v diplomové práci je získán od držitele licence e University of Iowa, College of Nursing v USA.
Sledované hodnoty
1. Subškála spokojenosti s vnějšími odměnami
2. Subškála spokojenosti v plánování
3. Subškála spokojenosti v rovnováze práce/rodina
4. Subškála spokojenosti se spolupracovníky
5. Subškála spokojenosti s interakcí na pracovišti
6. Subškála spokojenosti s možnostmi profesního růstu
7. Subškála spokojenosti s pochvalou, uznáním
8. Subškála spokojenosti s kontrolou a zodpovědností
9. Subjektivní pocit uspokojování motivačních faktorů
Vyhodnocení a diskuze V diskuzi byly diskutovány výsledky kvantitativního výzkumného šetření
38 florence 3/23
Mgr. Daniela Gajdová, Anesteziologicko-resuscitačního oddělení, Nemocnice Karviná-Ráj
studium a výzkum
Culle per la vita
Slovo babybox je významově neologizmus, nebo chcete-li pseudoanglicizmus, a do českého jazyka se dostává počátkem 21. století. Není snad nikdo, kdo by význam tohoto slova neznal, ať už mezi laickou, či odbornou veřejností. Pokusme se napříč historií pátrat po souvislostech, které ovlivnily dnešní podobu babyboxů neboli schránek pro nechtěné děti.
PhDr. Bára Svátková-Kvapilová, Vysoká škola zdravotnická, o. p. s., FNKV, Praha
Pravděpodobně prvním odloženým dítětem byl v 2. tisíciletí př. n. l. samotný Mojžíš. Z biblických textů se dočítáme o nařízení faraona o zabíjení izraelských novorozeňat mužského pohlaví z důvodu možné převahy při válečných taženích, a to vhozením do řeky Nil. Hebrejská matka chránila a ukrývala synka tři měsíce, a až poté poslala kojence v ošatce po Nilu, kde jej nalezla faraonova dcera a následně ho přijala za svého syna. Dostal jméno Mojžíš, což v překladu znamená „z vody vytažený“. Tento biblický příběh má v rámci možností dobrý konec, ne tak už pro nechtěné, nemocné, nedonošené malé Římany, kteří se odkládali nejčastěji v hliněných nádobách na tržištích. Bylo to i z toho důvodu, že vraždy dle římského práva byly sice trestné, ale odložení dítěte nikoli. Přímo v Římě byl často pro takové účely využit Mléčný sloup (Columna Lactaria), který byl nedaleko fóra. I když se děťátka mohl ujmout kdokoli, nemusel být jeho osud nadále příznivý, neboť mohl skončit dle vizigótského práva jako otrok nálezců. Změna k lepšímu nastává s nástupem katolické církve. Ale nepředbíhejme.
Zmínky o prvním útočišti nechtěných dětí pochází z Cařihradu, a to z roku 335 n. l. Obdobně na tom byla Francie, kde jsou již v 5. století zbudovány mramorové mísy, do kterých u klášterů a speciálních nalezeneckých domů mohou matky nechtěné děti odkládat. Ovšem legalizace takových zařízení se datuje až do 10. století. V Miláně bylo v roce 787 n. l. postaveno takzvané Xenodochium, což byl první dům na území Itálie sloužící k odložení dítěte. Po Miláně vzniká obdobné zařízení i v Římě, Neapoli či Florencii. Říkalo se jim Kolébky pro život – Culle per la vita. „Kolébky“ se podobou přiblížily současným babyboxům v Itálii až ve 12. století. Loutharius Segni, v letech 1198–1216 papež katolické církve Inocenc III., roku 1198 nařídil postavit v Římě nalezinec při Nemocnici sv. Ducha. Tato „kolébka“
už byla vybavena otočným mechanizmem směrem do vnitřního prostoru nemocnice či kláštera (nejčastěji u jejich dveří a bran) se zvonečkem, tak aby se jeptišky mohly o dítě co nejrychleji postarat.
Z dalších států, které se zapsaly do historie novodobých babyboxů, můžeme jmenovat například Rusko, Německo, Velkou Británii či Brazílii.
Po 1. světové válce se v Rusku začala objevovat zařízení pravoslavného typu s možností skrytě spustit šachtou děťátko do otvoru v zemi (tzv. monastýry). Posléze se o něj již postaraly
monašky, tedy obyvatelky klášterů východní křesťanské církve (například církve pravoslavné).
Vznik prvních babyboxů na území Německa datujeme na počátek 14. století, a to prvně ve městech Kolín a Ulm. Následně holandský misionář v roce 1709 zbudoval speciální schránky ve městě Hamburk. Ovšem po pouhých pěti letech byl nucen schránku zrušit, neboť odložených dětí bylo tolik, že jeho finanční prostředky nepostačovaly k pokrytí nejnutnějších nákladů na zaopatření všech odložených dětí. V roce 1764 byla nainstalována schránka ve městě Kastelu a bezmála za 50 let další schránka ve městě Mohuč. Těmto schránkám se v Německu říká „Babyfenster“ či „Babyklappe“.
Francii jsme již výše přiřkli určité prvenství v této problematice, na které navázala takzvaná „Věž pro opuštěné“.
Ta byla zřízena v roce 1638 v kostele Saint Vincent de Paul. Ovšem počet odložených dětí i zde velmi záhy narůstal (prameny hovoří i o 50 tisících za rok). Proto zařízení musela být z nedostatku finančních prostředků po více než 200 letech uzavřena. Nahradila je takzvaná příjímací kancelář fungující na principu anonymity. Matka zde mohla nejen bezejmenně odložit dítě, ale ještě byla edukována, jak má postupovat dále.

I Napoleon Bonaparte se zapsal do historie babyboxů předcházejících
Obrázek 1 Columna Lactarie (Mléčný sloup) v Římě


Obrázek 2 Kolo nalezenců, Nemocnice Santo Spiriti, Vatikán
Obrázek 3 Ospedale degli Innocenti (Špitál neviňátek), náměstí Piazza Santissima Annunziata, Florencie
42 florence 3/23
fota: www.romanoimpero.com, https://epochaplus.cz, Wikipedia historie
Komunikací k novému životu
Jak je důležitá komunikace zdravotnického personálu s pacienty? Slova přece nic nestojí.
Slávka Drgová, praktická sestra LDN Klokočov, FN Ostrava studentka 2. ročníku Slezské univerzity v Opavě – obor všeobecná sestra
Dobrý den pane Nováku,“ mile zdravím nově hospitalizovaného pacienta, který se na mě dívá nervózním a ustrašeným pohledem. Tiše odpovídá „dobrý den“, klopí oči, jako by se styděl, ale domnívám se, že se v něm ozývá nervozita z nového prostředí, ze setkání se zatím bezejmennými pacienty a pro něj i s novým personálem.

Takto vnímá nové prostředí nejspíše každý z nás. Pomáhám pacientovi s vybalením věcí, seznamuji a edukuji ho o chodu našeho oddělení. Pacient má 64 let a je přijat po operaci pravé dolní končetiny. V tuto dobu nás sanitáře bude potřebovat k dopomoci při všech denních úkonech, než bude schopen se o sebe po probíhajících rehabilitacích starat sám.
Pracuji v našem zařízení na pozici sanitář a poskytuji pacientům ošetřovatelskou péči. Samozřejmě se opakovaně blíže setkávám i s panem Novákem. Začínáme si povídat o počasí, o tom, jak se mu u nás líbí, zda je spokojen se stravou. Prostě klasický rozhovor dvou neznámých lidí, kterým by bylo ticho nepříjemné. Postupem času získávám odvahu zeptat se, „Pane Nováku, kde pracujete, copak děláte?“ a pan Novák sedí na posteli, zvedne oči směrem ke mně a odpovídá „Já nyní nepracuji. Pracoval jsem jako ARO lékař.“ V tu chvíli na něj zírám, asi dost dlouho, protože se mi hlavou honí myšlenky, že takových rádoby „lékařů“ jsem tady už viděla hodně. Vzhledem k mé pozici jsem nebyla dostatečně seznámena s tím, že pan Novák říká pravdu. Tento den jsem už po minulosti lékaře více nepátrala, ale samozřejmě mě zajímalo, zda pán mluví pravdu, nebo si možná
myslí, že je lékař.
Právě tou dobou jsem studovala na Mendelově střední škole v Novém Jičíně obor praktická sestra ve večerním studiu a ve škole jsme si povídali o hydrocefalu. Říkám si, že si vyzkouším pana doktora. Pokud je opravdu lékař, přece jen by mi mohl k této problematice něco říct. Příští směnu
přicházím za panem Novákem. „Dobrý den, jak jste se vyspal?“ začínám pomaloučku. Než se dostanu k jádru tématu, povídáme si o běžných věcech a já se začnu vyptávat. „Pane Nováku, prosím, jak to je s tím hydrocefalem?
Mluvili jsme o něm ve škole a asi mi unikly nějaké informace. Mohl byste mi o tom něco povědět?“ V tu chvíli jsem nevěřila svým uším, pan doktor začal popisovat příznaky, diagnostiku, léčbu… pro mě téměř vše v latinské terminologii. V tuto chvíli jsem uvěřila, že přede mnou sedí skutečný lékař. Tak to šlo postupně dva měsíce, kdy jsme si povídali a on mi pomáhal pochopit funkci orgánů našeho těla. Jednou jsem sebrala odvahu a říkám. „A proč už nejste lékař?“ A vyslechla jsem si jeho příběh.
„Pracoval jsem jako ARO lékař, bydlel jsem s matkou, se kterou jsem měl velmi krásný vztah. Stihl jsem se oženit, děti jsme s manželkou neměli, věnovali jsme se spíše vzdělávání a kariéře, to nám stačilo ke společnému životu. Do té doby než mi matka zemřela. Nedokázal jsem tuto skutečnost přijmout. Začal jsem brát léky, abych byl psychicky v pořádku. To mi ale časem přestávalo stačit, vím, že jsem udělal chybu, když jsem poprvé prášky zapil alkoholem, ale v tu chvíli bylo vždy mé trápení pryč. Žil jsem se závislostí dlouhou dobu, byl jsem si vědom, že takto dále nemohu pracovat. Měnil jsem zaměstnání, stále ve zdravotnictví, ale vždy o pozici nižší a nižší. No, ale jak to většinou v životě bývá, vše zlé má svůj konec. Já byl ten zlý. Se ženou jsme se rozvedli, společné majetky prodali a já byl z práce takzvaně odejit. S kapsou plnou peněz se mi zdál život jednoduchý, žil jsem z nich. Ale jednoho dne peníze došly.
Po bývalých kamarádech se slehla zem. Když jsem byl doktorem, měl jsem spoustu přátel. Když jsem pak ale potřeboval pomoc, nezbyl mi ani jeden. Neměl jsem kde bydlet, spal jsem v maringotce na fotbalovém hřišti, které se nyní opravuje, takže jsem nakonec velmi rád, že jsem tady a mohu zde žít nějakou dobu v teple, s jídlem a se střechou nad hlavou.“ Utichne a zahledí se do prázdna, nejspíše se mu celý příběh promítal znovu před očima. Jsem potichu, koukám na něj a je mi ho v tu chvíli líto, i když si uvědomuji jeho podíl viny.
Přichází další den… „Dobrý den pane Nováku,“ říkám s úsměvem, chci se Vás zeptat, „chtěl byste být znovu lékařem?“ Odpovídá ano, a tak navrhuji, že mu sepíšu e-maily do nemocnic a rozešlu je s tím, že se uchází o práci lékaře. V e-mailech popisuji skutečnost, závislost na prášcích, na alkoholu i to, že je ochoten se nechat přezkoušet komisí, která ohodnotí jeho znalosti a kvality.
Ozývá se nemocnice, má zájem se s panem doktorem sejít. Zařizuji doktorovi odvoz k jeho nové naději. Přichází k pohovoru, kde jiní lékaři zjišťují jeho vědomosti a dovednosti. Pan doktor zkouškou prochází na výbornou a sepisuje se pracovní smlouva na pozici lékaře v akreditovaném pracovišti nemocnice.
Získává novou šanci pro život. S novým zaměstnáním mu je nabídnut i byt, který je v areálu nemocnice. Byt je skromně zařízený, společně zde stěhujeme jednu velkou tašku a batoh, který nese pan doktor na zádech. To je vše, s čím vykračuje k novým lepším zítřkům.
Již je to více než dva roky, kdy pan doktor poskytuje lékařskou pomoc všem příchozím nemocným. Kolika lidem dokázal jeho nový život pomoct? Jsou to desítky? Stovky? Jsou mezi nimi členové našich rodin, naši přátelé? Stačilo tak málo, jen si začít povídat. Slova přece nestojí nic. Tak je, sestřičky, ošetřovatelé, sanitáři, používejme. Pak je již na každém z nás, jak s danými informacemi naložíme.
Slavka Drgová
Studentka Slezské univerzity v Opavě, praktická sestra v LDN Klokočov – Fakultní nemocnice Ostrava.
Zdravotnictví a práce sestry ji lákaly od dětství, ale na přání rodičů studovala gymnázium. Po letech se ale přece jen vydala svou cestou, její děti-dvojčata byly již odrostlejší, starší syn studoval na střední zdravotnické škole a i díky tomu se rozhodla splnit si svůj sen a začít studovat ve zdravotnictví – vysněnou sestru. Nyní je studentkou 4. semestru vysoké školy v oboru všeobecná sestra a příští rok jí bude 50 let.
45
dopis redakci
právní poradna
Jak to má běžný občan s povinností poskytnout první pomoc?
Odpovězme si na otázku, jakou odpovědnost za nesprávné poskytnutí první pomoci má běžný občan, tedy nikoli zdravotník.
JUDr. Jana Palečková, www.pravniporadkyne.cz

„Setkala jsem se s tím, že náhodný svědek komplikovaného úrazu na lyžích tvrdil, že kdyby udělal chybu, mohlo by mu hrozit vězení. Podle mě neměl pravdu, ale znejistěla jsem…“ (Anna K., Liberec)


Povinnost poskytnout první pomoc opravdu není absolutní. Ze zákona platí jen při přímém ohrožení života nemocného nebo při vážné nemoci nebo úrazu. Ovšem jiné to je na silnici. Jestliže jsme účastníci dopravní nehody, jsme povinni poskytnout první pomoc vždy. Trestné je už samo neposkytnutí, a to bez ohledu na to, zda dotyčný skutečně nějakou pomoc potřeboval. Řečí zákona tedy platí:
→ Trestný čin neposkytnutí pomoci podle § 150 trestního zákoníku (trestní sazba až 2 roky) spáchá ten, „kdo osobě, která je v nebezpečí smrti nebo jeví vážné známky poruchy zdraví nebo jiného vážného onemocnění, neposkytne potřebnou pomoc, ač tak může učinit bez nebezpečí pro sebe nebo jiného“.








→ Trestný čin neposkytnutí pomoci řidičem dopravního prostředku podle § 151 trestního zákoníku (trestní sazba až 5 let nebo zákaz činnosti) „spáchá řidič dopravního prostředku, který po dopravní

nehodě, na níž měl účast, neposkytne osobě, která při nehodě utrpěla újmu na zdraví, potřebnou pomoc, ač tak může učinit bez nebezpečí pro sebe nebo jiného“.
Odpovědnost za chybné poskytnutí pomoci
Obava z vězení kvůli chybnému poskytnutí pomoc je při dodržení zásady „rozumné přiměřenosti“ zbytečná. Pokud se pokoušíme zachránit život, nikdo nám nic nemůže právně ani morálně vyčítat. Výjimkou by snad mohl být jen případ, kdy bychom chtěli první pomoc poskytovat násilím nebo proti vůli postiženého. Zkrátka a dobře: pokud je postižený zjevně ohrožený na životě, tedy silně krvácí, nedýchá, je v bezvědomí apod., můžeme si dovolit téměř cokoli, na druhou stranu v situaci, kdy nic z toho nehrozí a postižený jasně deklaruje, že si naši pomoc nepřeje, měli bychom se držet zpátky.
Pro vznik trestní odpovědnosti vždy platí, že ten, kdo by měl být odpovědný, musí svým jednáním naplnit skutkovou podstatu trestného činu. Měl by zavinit, ať už úmyslně nebo neúmyslně, ale i z laického pohledu zjevně škodlivě, nějaký následek. I čin z nedbalosti vyžaduje, aby viník buď věděl, že může následek způsobit, ale nedbal toho, anebo sice nevěděl, ale vědět měl a mohl. Zachránci tedy sice nelze zaručit úplnou beztrestnost v případě, že se při poskytování
Co je Pravniporadkyne.cz
Informační a poradenské centrum www.pravniporadkyne.cz se věnuje oblasti zdravotnického práva a navazujících částí sociálního zabezpečení. V rámci svých služeb poskytuje workshopy a školení pro veřejnost i zdravotnický personál.
první pomoci dopustí chyby, ale musí jít o chybu, která je jasně poškozující a zřejmá i laikovi. Pokud to tedy shrneme: je velmi obtížné představit si jakýkoli druh právní odpovědnosti v souvislosti s poskytnutím první pomoci, jestliže při ní postupujeme s dobrou vůlí a rozumem.
Někdy je zákon dokonce možné překročit
Při poskytování první pomoci se můžeme dostat do situace, kdy prostě musíme zákon porušit a kdy může například vzniknout škoda na cizím majetku. Náš právní řád na tyto situace pamatuje institutem takzvané krajní nouze (§ 28 trestního zákoníku, § 2906 a § 2907 občanského zákoníku). Pokud někdo odvrací hrozící nebezpečí a způsobí při tom škodu či poruší zákony nebo jiné předpisy v míře, která není nepřiměřená možnému ohrožení, trestní ani jiná odpovědnost nevzniká.
Převedeno do praxe: jestliže vážně zraněnému při poskytování první pomoci někdo roztrhne oděv, rozbije mu okénko auta, vypáčí drahé vstupní dveře rodinného domu, za škodu neodpovídá. Pokud např. pro transport postiženého do nemocnice použije vlastní automobil, protože záchranná služba není z jakéhokoli důvodu k dispozici nebo je vytížená jinými pacienty, má právo i na náhradu nákladů, které takto vzniknou (provozní náklady, vyčištění auta apod.). Své nároky však zachránce musí aktivně uplatnit.
Následek, který by hrozil, kdyby zachránce takto nejednal, musí být však vyšší než způsobená škoda. Nelze tedy obhájit nadměrně rychlou jízdu do nemocnice s člověkem, který má vyvrtnutý kotník nebo je mu prostě jen špatně. Na druhou stranu souseda, který má zjevné příznaky infarktu a záchranná služba je v daný okamžik z jakéhokoli důvodu nedosažitelná, můžeme odvézt do nemocnice i pod vlivem alkoholu, aniž bychom se dopustili trestného činu. Pro cestu zpět však tato výjimka už neplatí.


46
JUDr. Jana Palečková
angličtina
Wound Care

If a wound care nurse is not available, the clinical nurse may be the first caregiver to assess changes in a patient’s skin. Managing theese changes, including wounds, can be challenging, as patients present with diverse disorders and tissue damage can range from superficial to deep. But by applying a few basic principles, starting with a skin and woundassessment, the nurse can simplify the process and determine an appropriate treatment plan.
Assessment basics
Successful wound management starts with a thorough assessment of the wound and periwound skin. e assessment should include the following components.
– Anatomic location. Location can provide information regarding possible causes of the wound. For example, a wound over the sacral area in a bedbound or immobile patient could be a pressure injury, a wound in a lower extremity with accompanying edema could be a venousulcer, and a wound on the plantar surface of the foot may be a neuropathic ulcer.
– Degree of tissue damage. Determining the degree of tissue damage in a wound will help to guide the care plan and will provide some information regarding the healing trajectory. Wounds can be described as partial thickness, with damage limited to the epidermal and/or dermal layers, or full thickness with damage evident in the subcutaneous layers and below.
– Type of tissue in the wound. Tissue in the wound bed can be described as viable or nonviable. Viable tissue can appear beefy red as with granulation tissue, or light pink in the case of new epithelial tissue. In contrast, the appearance nonviable or necrotic tissue varies: eschar may be black, brown, or tan; fibrin slough is described as stringy or adherent and yellow in color.
– Wound size. Describe the size of a wound according to lineardimensions (length times width). Measure a wound’s length using the head-toe axis; measure its width from side to side. If the wound has depth, measure from the deepest point of the wound to the wound surface using a sterile cotton-tip applicator.
SLOVNÍČEK
wound – rána; zranění
caregiver – pečující tissue – tkáň
superficial – povrchový; povrchní wound assessment – hodnocení rány to determine – stanovit; určit; zjistit thorough – důkladný; pečlivý; svědomitý periwound (peri-wound) – tkáň obklopující
ránu
bedbound – upoutaný na lůžko extremity – končetina
Look at the whole picture




Because wounds do not occur in isolation, wound management involves not only the topical care, but also attention to other systemic or local factors that can be contributing to wound development or impaired healing. Consider the following:
– In the case of pressure injuries, minimizing pressure and shear must be part of the treatment plan.
– With neuropathic wounds, decreasing the risk of further injury, especially in patients with diminishedsensation, is an important educational intervention.
– Controlling lower extremity edema in patients with venous ulcers through compression is a fundamental component of a successful treatment plan. Compression dressings and multilayer bandaging systems are the gold standard for venous ulcers.
– Establishing adequate perfusion to the extremity in patients with arterial ulcers is essential to wound healing. Some patients will need revascularization to support healing.
– In patients with skin tears, protecting the skin is a priority, especially in those with fragile skin or other risk factors.
– In patients with a history of diabetes mellitus, glycemic control is an important factor to consider in wound development and wound healing.
Nutrition is another component of an overall wound treatment plan. e prevalence of malnutrition in the hospitalized population has been cited as between 30% and 50%. Nutrition and hydration are essential to normal cellular function and successful wound healing. Assessing the patient’s nutritional status in consultation with the registered dietitian is essential to determine the patient’s potential to heal. A nutritional plan should take into consideration the patient’s overall health and nutritional status and include appropriate nutritional and micronutrient supplementation. For example, in patients with pressure injuries, 30 to 35 kcal/kg of body weight is recommended daily, as is 1.25 to 1.5 g/kg of protein daily and micronutrient supplementation in patients who have a known or suspected vitamin deficiency.
venous ulcer – žilní vřed subcutaneous – podkožní nonviable – neživotaschopný slough – strup linear dimensions – lineární rozměry axis – osa to contribute – přispět; podílet se to impair – narušit; zhoršit; poškodit to diminish – snížit sensation – citlivost, cit multilayer – vícevrstvý appropriate – odpovídající; vhodný; náležitý
Source: COX J. Wound care 101. Nursing 2019; 49(10): 32–39. doi: 10.1097/01. NURSE.0000580632.58318.08. (shortened)
Objednejte si předplatné časopisu Florence
Podpořte jediný odborný časopis, který „pro vás o vás“ na českém trhu vychází.
Standardní roční předplatné Časopis vám doručíme přímo na zaslanou adresu, poštovné hradíme my.
Bližší informace o předplatném najdete na: https://www.florence.cz/ o-nas/predplatne/
Redakční rada časopisu Florence a vydavatelství Care Comm s.r.o. vyhlašují
soutěž o nejlepší původní práci časopisu Florence 2023
Zařazeny budou všechny původní práce a kazuistiky přijaté v recenzním řízení v roce 2023.
Nejlepší práce bude vybrána redakční radou Florence a ohodnocena věcnou cenou a finanční dotací.
Práce musí splňovat podmínky dle pokynů pro autory dle www.florence.cz. Práce zasílejte na e-mail: marketa.zbrankova@carecomm.cz.
www.florence.cz/ Adresa redakce: Klicperova 604/8, 150 00 Praha 5, e-mail: florence@carecomm.cz, tel.: +420 222 352 573 / Šéfredaktorka: Mgr. Markéta Zbranková, e-mail: marketa.zbrankova@carecomm.cz / Jazyková redakce: Mgr. Irena Kratochvílová, Mgr. Lucie Pokorná, Ing. Jaroslav Zámečník / Grafická úprava: Karel Zahradník / Redakční rada: PhDr. Martina Šochmanová, MBA, předsedkyně, Mgr. Hana Svobodová, Ph.D., Mgr. Lenka Gutová, Mgr. Tamara Starnovská, Mgr. Helena Michálková, Ph.D., RNDr. Romana Mrázová, Ph.D., Mgr. Radomír Vlk, DiS., PaedDr. Jan Polák, CSc., PhDr. Mgr. Michaela Hofštetrová Knotková / Vydavatel: Care Comm s.r.o., www.carecomm.cz / Jednatel společnosti: Martin Koblasa / Obchod: Simona Dorňáková, tel.: +420 731 202 341, e-mail: simona.dornakova@carecomm.cz / Personální inzerce: Nikola Janková, tel.: +420 608 848 496, e-mail: niki.jankova@carecomm.cz / Tisk: AKONTEX s.r.o., Zárybničná 2048/7, Praha 4 / Distribuce: Postservis Praha a Mediaprint-Kapa Pressegrosso, a.s. / Cena výtisku: 75 Kč / 4,50 EUR, roční předplatné: 450 Kč / 23,40 EUR / Časopis vychází 6× ročně / Registrace: MK ČR-E 16134, ISSN 1801-464X / Kontakty pro předplatitele: Česká pošta, s. p., oddělení periodický tisk, postabo.prstc@cpost.cz, tel.: +420 800 300 302 /Přetisk a jakékoliv šíření je povoleno pouze se souhlasem vydavatele. Nevyžádané příspěvky se nevracejí. Redakce neodpovídá za jazykovou správnost inzerátů. / Copyright © Care Comm s.r.o., 2023


48 florence 3/23
450 Kč